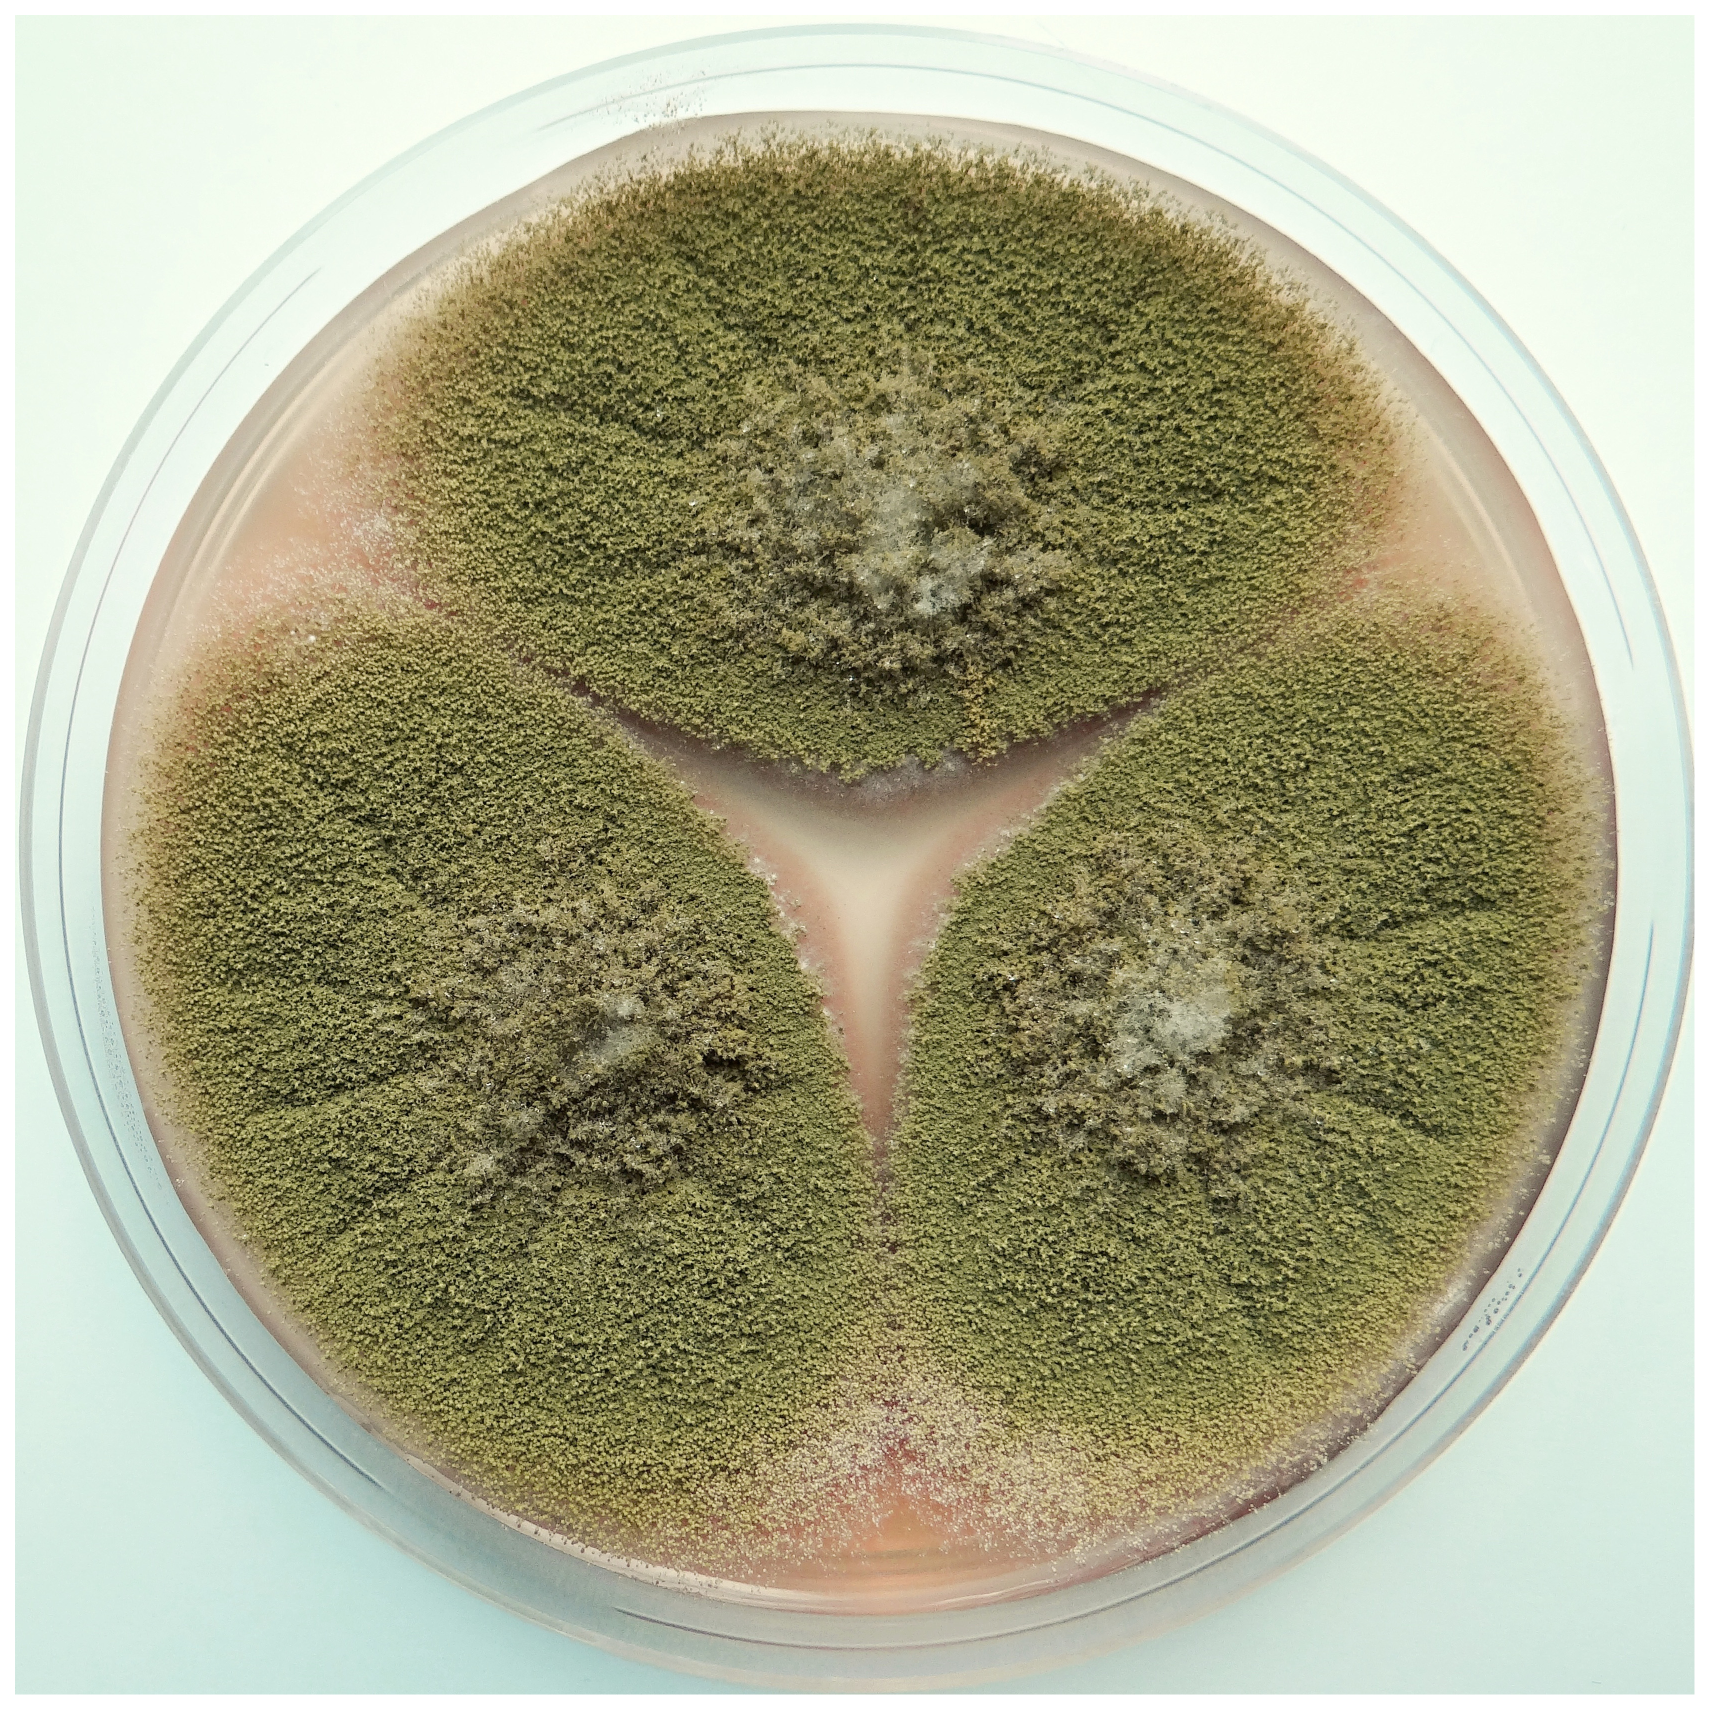
Toxins 13 00399 g002

Abstract
In the early 1960s the discovery of aflatoxins began when a total of 100,000 turkey poults died by hitherto unknown turkey “X” disease in England. The disease was associated with Brazilian groundnut meal affected by Aspergillus flavus. The toxin was named Aspergillus flavus toxin—aflatoxin. From the point of view of agriculture, aflatoxins show the utmost importance. Until now, a total of 20 aflatoxins have been described, with B1, B2, G1, and G2 aflatoxins being the most significant. Contamination by aflatoxins is a global health problem. Aflatoxins pose acutely toxic, teratogenic, immunosuppressive, carcinogenic, and teratogenic effects. Besides food insecurity and human health, aflatoxins affect humanity at different levels, such as social, economical, and political. Great emphasis is placed on aflatoxin mitigation using biocontrol methods. Thus, this review is focused on aflatoxins in terms of historical development, the principal milestones of aflatoxin research, and recent data on their toxicity and different ways of mitigation.
Key Contribution:
In the year 2020 it was exactly 60 years since aflatoxins were discovered. For humans, aflatoxins are considered the most important and deleterious mycotoxins. Aflatoxins are among the five most important mycotoxins in agriculture. The numerous effective pre-harvest and post-harvest biocontrol methods to aflatoxin mitigation have been applied. Therefore, worldwide, aflatoxins pose an ongoing and still unsolved problem.
1. Introduction
In 2020, it was 60 years since the discovery of aflatoxins (AFs). AFs began the “second mycotoxicology era” that built on the “previous mycotoxicology era”, e.g., ergotism, acute cardiac beriberi, alimentary toxic aleukia, stachybotriotoxicosis, “mouldy corn toxicosis”—equine leucoencephalomalacia [1,2,3,4].
2. A History of Aflatoxin Discovery
In the late 1950s and early 1960s, a new so far unknown turkey disease, characterized by heavy mortality, was identified in England. After the turkey disease outbreak of unknown nature and aetiology (the turkey “X” disease), the discovery of AFs began. A total of 100,000 turkeys died of so-called turkey “X” disease after being fed with contaminated Brazilian groundnut meal on a poultry farm in London [5].
William Percy Blount (Figure 1) was a veterinary scientist and consultant in poultry husbandry and developed a highly effective poultry disease diagnostic service for the customers of a major feed compounding company in England.
Figure 1.
William Percy Blount (*1905–+1968). Photo: World’s Poultry Science Association.
Chief poultry advisor W.P. Blount carried out intensive field and laboratory research, the findings and conclusions of which were published the following year [5]. Many affected turkeys were about 4–6 weeks old, but others were aged 10–16 weeks. Affected turkeys naturally sought the heat of their brooders and then, through weakness, they would sink to the floor and become somnolent, death taking place within 24–48 h. Another characteristic of the disease was the position or the posture adopted by the poults when they died. Mortality varied but was usually high, often with death rates of 50–90% [5]. By the time the disease had subsided, about 500 outbreaks had been reported involving an estimated loss of over 200,000 turkeys [6].
A causal relationship between feed toxicity, Brazilian groundnut meal, and disease has been demonstrated by W.P. Blount, who accurately described the symptoms, especially liver lesions, and subsequently excluded that the disease could be the cause of the infectious agents. The turkey “X” disease had to be differentiated from Non-specific enteritis, Transmissible enteritis, Infectious hepatitis, Newcastle disease, New “virus” infection, and “poisoning” (bacterial, fungal, mineral, vegetable, etc.). Because veterinary examinations for pathogenic microorganisms were generally negative, and as the epidemiological picture was not that which might be associated with an “infection”, the final possibility that the turkeys were “poisoned” remained. The histological findings, post mortem in young turkeys that had died suddenly were described in detail in other studies. They also suggested that the disorder was caused by poisoning, but the toxic substance had not been identified [7,8].
W.P. Blount had also excluded the participation of chemical agents and potentially toxic chemicals that are commonly found in poultry feed, either as contaminants (e.g., toxic elements, pesticides, glycosides, alkaloids, natural phytotoxins, etc.), ingredients (a toxic compound in Brazilian groundnut meal), or as a result of dishonest practices. Although his efforts did not lead to the identification of a causative factor, he provided a solid basis for peer scientists to make relatively rapid progress towards the goal [5].
The disease continued in the same area of London and induced deaths among turkeys on farms as a result of previous feeding with Brazilian groundnut from mills carried by the same company, which included groundnut in the composition of the feed. Groundnut meal was later proved as the main suspect [6,9,10,11]. Similar liver lesions, considered to be the most serious damage, were found during post mortem examination tests on ducklings, chicken, young pheasants, cattle, rats, and pigs fed with Brazilian groundnut meal [6,9,10,12,13].
The rats fed on groundnut meal showed toxic effects with the development of liver cancer [14,15], which was later confirmed by several studies [16,17,18,19]. An investigation of the peanut meal determined that it was highly toxic, with a naturally occurring toxic metabolite produced by mold infestations that caused the acute toxic effects in the animals [9]. Although it had been suspected since the end of 1960 that the cause might be a toxin [10], this was not finally established until the end of the following year when it was demonstrated that metabolites synthesized by some strains of Aspergillus flavus Link ex Fries were responsible [20]. Mold contaminant of Aspergillus flavus Link ex Fries was identified in the Central Veterinary Laboratory at Weybridge in England. A replica of A. flavus identification is shown in Figure 2 and Figure 3.
Figure 2.
Macroscopic view of Aspergillus flavus on Czapek yeast extract agar (25 °C, 7 days). Photo: Vladimir Ostry.
Figure 3.
Light microscopy of Aspergillus flavus with lactophenol cotton blue. Photo: Vladimir Ostry.
Selected isolates of A. flavus were cultivated on mycological media under laboratory conditions. The cultures with overgrown mycelium of A. flavus were extracted with CHCl3. Paper chromatography was used in this experiment with the mobile phase butan-1-ol: CH3COOH. A total of 12.5% of tested extracts emitted a blue fluorescence spot (retention factor (Rf) value of 0.7) under UV light. After oral administration of the corresponding extract to one-day-old ducklings, death was observed within 24 h due to typical symptoms of turkey “X” disease, especially liver damage [10].
The isolation of the toxin crystalline form responsible for the turkey “X” disease has been performed [21]. Because the extract was poorly pure, the blue fluorescent spot probably contained more toxic metabolites. After separation and quantification by thin layer chromatography, two different fluorescent spots were detected, the former emitting blue (Rf 0.6) and the latter emitting green (at slightly lower Rf) fluorescence. Aspergillus flavus toxin gave rise to the name aflatoxin. The name aflatoxin was given to the toxic substance, which has since been found to contain several closely related toxic components.
AF discovery was a collective effort, involving a number of experts from various fields of research in veterinary medicine, animal nutrition, toxicology, chemistry, and mycology, and etc.
3. The Milestones in Aflatoxin Research
Research on AFs in all areas of interest is very extensive. Several valuable reviews on AFs have been published in the last decade [1,4,22,23,24,25,26,27,28,29,30].
These primary and valuable articles served to prepare the principal milestones of AF research. The older data from the years 1960 to 1990 were independently confirmed. Studying the principal milestones allows us to present an overview from several fields of research on AFs from their discovery to 2021.
Figure 4.
The milestones in aflatoxin research over the years 1960–1970 [5,9,11,12,13,14,15,17,19,20,21,31,32,33,34,35,36,37,38,39,40,41,42,43,44,45,46,47,48].
Figure 5.
The milestones in aflatoxin research over the years 1971–1990 [49,50,51,52,53,54,55,56,57,58,59,60,61,62,63,64,65].
Figure 6.
The milestones in aflatoxin research over the years 1991–2005 [66,67,68,69,70,71,72,73,74,75,76,77,78].
Figure 7.
The milestones in aflatoxin research over the years 2006–2021 [26,79,80,81,82,83,84,85,86,87,88,89,90,91,92,93,94,95,96,97,98].
4. Recent Data on Aflatoxin Toxicity
The human population is often exposed to low AF levels due to the daily intake of various AF-contaminated products [99]. Approximately 4.5 billion people worldwide, mainly in developing countries, have been estimated to be chronically exposed to AFs via contaminated food [100,101]. Moreover, due to the difficulties in food management and the socio-economic difficulties caused by the ongoing coronavirus pandemic (COVID-19), an increase in the consumption of AF-contaminated foods can be expected [102]. In 2020 according to the RASFF (Rapid Alert System for Food and Feed) database, AFs were the most often notified in peanuts; dried figs; spices; rice; and various nuts such as hazelnuts, almonds, and pistachios [103]. However, in recent years, some of these food products have shown a relatively high concentration exceeding 1000 µg/kg [103], which may be related to the development of aflatoxicosis, which can lead to serious health problems, in particular damage to the liver and other organs, primary liver cancer, and even death [104].
AFs are infamous for their high toxicity, therefore their presence in food (and feed) is highly feared. Naturally occurring AFs (AFB1, AFB2, AFG1, and AFG2) act as strong carcinogens, thus they are assigned into Group 1 “carcinogenic to humans” by the International Agency for Research on Cancer (IARC) [84,105]. Apart from their carcinogenicity, they have been reported to have mainly hepatotoxic, genotoxic, mutagenic, teratogenic, immunosuppressive, nephrotoxic, and cytotoxic effects [106,107,108,109].
Some toxic effects of AFs have been observed in the most recent literature. Hepatotoxic effect of AFB1 has been demonstrated in vivo on mice [110,111], rats [112], rabbits [113], and broiler chickens [114]. The nephrotoxic effect of AFB1 has been reported in vivo on broiler chickens [114] and rats [112]. The neurotoxicity of AFB1 has been observed in vitro on human astrocytes and in vivo on a glial cell in zebrafish [115]. The immunosuppression of AFB1 has been demonstrated in vitro on swine alveolar macrophages [116]. Reproductive toxicity of AFB1 has been demonstrated in vivo on mice [110]. Pulmonary toxicity of AFB1 has been observed in vivo on male albino rats [117]. Gastrointestinal toxicity of AFB1 has been described in vivo on rats [118], pigs [119], and chickens [120]. The genotoxic effect has been observed in vivo on mice [110]. Cytotoxic and/or genotoxic effects of AFB1 have been reported in vitro on the leghorn male hepatoma (LMH) cell line [121], the liver hepatocellular carcinoma (HepG2) cell line [122], buffalo rat liver (BRL-3A) cells [123], bovine mammary epithelial (BME) cells [124], and the human keratinocyte (HaCaT) cell line [125]. Cytotoxicity on BME cells has also been observed in vitro in the case of AFM1 [124]. The embryotoxicity of AFB1 has been reported in vitro on bovine embryos [126].
It should be emphasized that the impact of AFs, as well as other mycotoxins or contaminants in general, on human health always depends on the toxicological properties of the agent, the individual properties of the consumer, and duration of exposure to the agent, and also the presence of other contaminants with which an interaction (e.g., synergistic) could occur [127].
4.1. Toxicological Interactions of Aflatoxins and Other Mycotoxins
Worldwide, food (and also feed) may be infested by more than one type of mold. Moreover, most molds can produce several mycotoxins simultaneously, as a result of which humans and animals may be exposed to a “cocktail of mycotoxins” in their diet [95,128,129]. However, the regulations worldwide do not take into account the combined effects of co-occurred mycotoxins [130]. Various interactions (synergistic, additive, antagonistic) have been reported, mainly between AFs and ochratoxin A (OTA), fumonisins, and trichothecenes [128]. AFs with fumonisins and AFs with OTA are among the most common mycotoxin combinations in cereals and cereal products [130].
For example, in the recent literature, the antagonistic effect on inducing cytotoxicity on the LMH cell line has been observed between AFB1 and OTA [121]. On the contrary, these two mycotoxins, also in combination with zearalenone (ZEA), acted synergistically in negatively affecting the milk production, blood metabolism, and immune function of Laoshan goats [131]. Synergistic interaction between AFB1 and OTA has also been observed in vitro on swine alveolar macrophages (3D4/21) [132]. A synergistic effect has also been reported between AFB1, deoxynivalenol (DON), and ZEA on human epithelial (Caco-2) cells [133]. However, reduced cytotoxicity of DON on the viability of MA-10 Leydig cells in vitro has been observed when combined with AFB1 [134]. A synergistic effect has also been observed within the AF group between AFB1 and AFM1 in compromising intestinal integrity in vivo on mice and in vitro on Caco-2 cells [135].
4.2. Toxicological Interactions of Aflatoxins with Other Contaminants
Humans (but also animals) can be exposed to many other environmental toxins along with mycotoxins, such as heavy metals and pesticides, but also algal toxins [95]. Considering that some mycotoxins and other environmental toxins may share the same target organ or tissue, the monitoring of their common combined effects pose a challenge for further research as these agents are usually studied individually rather than in combination [95]. However, there are several recent studies that address the interaction of AFs with other contaminants.
Heavy metals such as nickel, arsenic, lead, chromium, mercury, and cadmium share the main target organ, liver, with AFs [96], and it is therefore important to research their interactions. In an in vivo study, AFB1 and cadmium chloride showed an additive interaction in inducing acute oral toxicity in kunming mice [136]. A synergistic effect of AFB1 and sodium arsenite has been observed, including cytotoxicity in vitro in urinary bladder (HUC-PC) cells [137].
The co-contamination of agricultural crops with AFs (and also other mycotoxins) and pesticides (insecticides, fungicides, herbicides) has been reported [95]. Therefore, due to their co-occurrence, it is necessary to consider their combined toxic effects. Recently, an antagonistic interaction between AFB1 and the insecticide chlorpyrifos has been observed on HepG2 cells for cytotoxicity and genotoxicity [122]. In the case of AFB1 and insecticide p,p’-DDT, a dose-dependent interaction has been observed on MA-10 Leydig cells in vitro—additive at doses of 16 µM (5671.84 µg/L and 4996.36 µg/L of p,p’-DDT and AFB1, respectively) and 32 µM (11,343.68 µg/L and 9992.64 µg/L of p,p’-DDT and AFB1, respectively) and antagonistic at 64 µM (22,687.36 µg/L and 19,985.28 µg/L of p,p’-DDT and AFB1, respectively) [134].
Microcystin-LR (MC-LR), a toxin that is produced by cyanobacteria Microcystis aeruginosa, has been observed to possibly increase the liver damage risk in people suffering from hepatitis B simultaneously exposed to AFB1 [94]. Enhanced effects of AFB1 and MC-LR interaction on genotoxicity and cytotoxicity have been observed on the human liver cell line (HL7702) in vitro [138]. In contrast, a recent study points to the possibility of an antagonistic effect of low levels of MC-LR on AFB1-induced hepatocarcinogenicity on HL7702 cells in vitro through decreasing CYPA1A2 expression and AFB1-DNA adduct generation, while demonstrating that exposure to a combination of MC-LR and AFB1 may not worsen liver damage compared to exposure to AFB1 alone on six-week old male Sprague-Dawley rats in vivo [139]. Additionally, the combination of AFB1 and MC-LR predominantly exerted antagonistic effects in cytotoxicity to HepG2 and Madin-Darby bovine kidney epithelial (MDBK) cell lines in vitro [140].
Apart from the above-mentioned contaminants, AFs can interact with many other toxic substances from the environment. For example, polychlorinated biphenyls (PCB) may potentiate/enhance the genotoxicity effect of AFB1 in the human hepatocyte line (L-02 cell line) by enhancing CYP1A1, CYP1A2, and CYP3A4 expression [141].
4.3. Toxicological Interactions of Aflatoxins with Hepatitis B and C Virus in Relation to Carcinogenicity
AFs may induce a number of cancer types (liver, breast, lung, gallbladder, esophageal), the best known of which is liver cancer [142]. Liver injury and hepatocellular carcinoma (HCC), one of the major types of liver cancer, are considered the main toxic impact of AFB1 [99,107,143,144]. Worldwide, approximately 5–28% of HCC occurrences are attributed to AF exposure [145]. Globally, a total of 905,677 new cases (corresponding to a crude rate of 11.6 cases per 100,000 people) and 830,180 deaths (corresponding to a crude rate of 10.7 cases per 100,000 people) due to liver cancer in both sexes and all ages were estimated in 2020. Based on the total number of cases, liver cancer is ranked the 6th and 3rd cancer type in incidence and mortality, respectively, worldwide [146]. More than 80% of HCC cases come from developing countries [147]. HCC has become a serious health problem, especially in sub-Saharan African countries and countries of southeast Asia, and it is also increasing in Europe and the United States [148,149].
Dietary exposure to AFs is considered the second largest environmental risk factor for liver cancer development [148] after viral hepatitis B or C infections [150], which act synergistically with AFs [149]. Especially in developing countries, hepatitis B is considered the main risk factor for HCC; however, dietary exposure to AFs also plays a significant role in HCC etiology [151]. A recent study on Iranian patients suffering from hepatitis B or C has demonstrated the potential involvement of AFB1 exposure as a mean risk factor in the HCC etiology in these patients [152]. Chronic hepatitis B virus infection may induce cytochrome P450s, which is responsible for the metabolism of non-toxic AFB1 to AFB1-8,9-epoxide (AFBO) metabolite, with highly toxic and mutagenic effects [153]. AFBO attacks DNA through binding to the N7 position of guanine residues to produce a pro-mutagenic unstable DNA adduct AFB1-N7-Guanin. This DNA-adduct induces a specific transverse mutation G:C to T:A at codon 249 of the tumor suppressor gene p53, which is involved in cell cycle regulation [149,154,155,156]. This mutation is typical for HCC patients from regions of high AF-exposure [149,155].
5. Recent Data on Aflatoxin Mitigation
Several valuable original research articles [157,158,159] and reviews [97,98,160,161,162,163] on AF mitigation have been published over the last three years.
AF mitigation means reducing the health risk from the occurrence of AFs in foodstuffs. AF mitigation is key to food safety and nutrition and is any process used to reduce AF concentrations in foodstuffs [164].
AFs represent a threat to food safety worldwide because they are considered to be among the most prominent and dangerous toxins that can affect any part of the food chain from pre-harvest to food processing. Prevention and mitigation of AF contamination is critical to protect consumers from the adverse health effects associated with AFs [161,165].
AF contamination arises at multiple points in the food system, from the field to the home (where pest attack or poor drying techniques and inadequate crop storage allow the A. flavus to grow), and to the marketplace (where lack of quality control allows contaminated food to be sold). It is important to equip producers, traders, and consumers with knowledge that can help them manage this issue [157,165].
The weather conditions prior to harvest play a cardinal role in the risk of AF production, and the globalization of trade flows, as well as climate change, lead to the occurrence of unexpected AFs in unusual products [166,167].
AFs present a significant health hazard to consumers. With the potential to contaminate a range of common foods and feeds, such as grains (wheat, corn, barley, rice, and oats), nuts, cocoa, and milk, AFs present an ongoing challenge to food safety all along the food chain. The ideal way to mitigate their risk to food safety is to prevent these toxins from entering the food chain at all, and a number of pre-harvest strategies based on good agricultural practices can help [103,164,165].
Even with the best prevention strategies, however, AFs can end up in the food chain given that they are ubiquitous worldwide and that ever-changing environmental conditions preclude strict elimination [157,163].
At the present time, to avoid unfavorable AFs effects on public health, great attention is being given to prevention as well as to pre-harvest methods intended for A. flavus contamination reduction [157,162,163,166].
Numerous post-harvest methods to combat AFs are also required, such as emerging physical methods (e.g., non-thermal treatments as pulsed electric fields), interventions with chemical agents (e.g., adsorbents, acids, enzymes, and gases), interventions with microbiological agents (e.g., bacteria, yeast and microfungi), and genetic engineering technologies. These methods have been reported to be effective in mycotoxin diminution in food and feed [97,98,160,161,162].
5.1. The Selected Effective Pre-Harvest Method for Aflatoxin Mitigation
A total of 22, 4, and 2 species of the genus Aspergillus from the Flavi, Nidulantes, and Ochraceorosei sections produce AFs, respectively, with A. flavus of section Flavi being the most important and best known species [103].
A. flavus may be divided to the L and S morphotypes. The S morphotype produces a lot of small sclerotia (average diameter <400 μm), few conidia, and a regularly high amount of AFBs [168]. In contrast, the L morphotype can produce less numerous, larger sclerotia (average diameter >400 μm), a lot of conidia, and mutable amount of AFBs. There are also L morphotype genotypes that are not able to produce AFs (i.e., non-aflatoxigenic) due to inversions, deletions, or defects in at least one of the AF biosynthesis genes (a single mutation in the pksA (aflC) gene of its AF pathway), which bring in a premature stop codon and cause it to be defective [169,170]. As a potential biocontrol agent, found in a peanut fields in Georgia, there is another non-aflatoxigenic A. flavus strain (NRRL 21882), which demonstrated an important effect against native aflatoxigenic strains in laboratory tests and is commercially known as Afla-Guard®. The complete absence of the AF gene cluster is responsible for its inability to produce AFs [170]. Further, in Italy, the biopesticide (AF-X1TM) was evolved for protection of fodder maize crops [171]. The biopesticide formulation (A2085) original used strain is comparable to NRRL 21882 due to AF gene cluster lacking. Mytoolbox Af01 is another commercial product with the biocontrol strain, with a partial-cluster strain, which successfully reduces AFs in Serbia maize, due to the lack of AF cluster genes from aflT to aflN [172].
All new findings of these defected non-aflatoxigenic A. flavus isolates support an AF biocontrol strategy development to mitigate the AF content in crop. This new effective technology was first used widely in the US. Nowadays, this environmentally friendly and safe technology is annually employed over hundreds of thousands of hectares of susceptible crops [157,159,166,170].
Under the commercial name AflasafeTH (sorghum seed as a carrier of the non-aflatoxigenic strain of A. flavus) this improved biocontrol technology has been used in sub-Saharan Africa for more than 13 nations (Burkina Faso, Burundi, Gambia, Ghana, Kenya, Malawi, Mozambique, Nigeria, Rwanda, Senegal, Tanzania, Uganda, and Zambia), where effort to evolve biocontrol products is relevant, and it can be assumed that the number of participating nations will increase. Especially in African countries, modern technologies have been used to produce low-cost AflasafeTH products via mass production. Registered experimentally, AflasafeTH products have been proven to reduce AF levels in treated crops (e.g., maize and groundnut) by more than 80% compared to untreated crops with the same storage and field conditions [157,159,166,170].
5.2. The Selected Effective Post-Harvest Methods for Aflatoxin Mitigation
5.2.1. Physical Post-Harvest Methods
Sorting
Most often, AFs contaminated grain is broken or damaged, which leads to inhomogeneous contamination of the entire volume of the stored crop; therefore, separation methods are suitable for decontamination [173]. Thus, sorting machines using the weight and size of particles as a parameter have been used for a long time. Airflow flotation and centrifugation used to be employed for sorting high volumes of grain, but sorting based on the optical principle was established in the 1960s. Due to the higher efficiency, this method is still used and is based on the principle of optical control when grains or peanuts are passing along the sensors. If a grain of a different color is detected, the magnetic valve opens and a thin stream of compressed air removes the grain [165]. For improvement of this currently used sorting method, for reduction of the risk of contamination, the single kernel sorting tool could be used for detection of multiple types of mycotoxins, including AFs, in peanuts and maize [174].
Dehulling
The precondition for the successful elimination of AF content is the restriction of colonization by AF-producing fungi on the surface layers of grains [165]. The outer layers of the grain are removed by dehulling techniques, which can remove up to 93% of the AFs [175].
Steeping
The first part of wet milling of maize grains, the steeping, consist of soaking the grains for 36–50 h at 50 °C in 0.1–0.2% SO2 water solution to disrupt protein matrix and improve germ separation and also induce production of lactic acid, which can be considered chemical treatment. The result is that the steeping liquor commonly obtains around half of the AF content [165,176]. Additionally, the level of AFs from sorghum grains could be decreased by steeping in 0.2% NaOH solution under levels of detection [177].
Wet Milling
Up to 40–50% of AFs could be eliminated from maize into the solution in wet milling; the remaining levels of AFs could be determined in the fiber fraction (28–38%), the gluten fraction (11–17%), germ (6–11%), and starch (1%) [165].
Dry Milling
Additional dry milling leads to the reduction of AF concentration in the germ fraction of the maize grain [165].
Heat Treatment
Temperatures above 160 °C have been shown to be effective in destroying pure AFB1, with soybean matrix accelerating the destruction process [178]. While temperatures up to 100 °C used for common food preparation have little effect on AFs, the higher temperatures used in frying, baking, roasting, and extruding may be more effective in reducing AF contamination [165].
AF levels can be decreased by extrusion by up to 50–80%, depending on the temperature and humidity of the grain, while the efficiency of the whole process can be increased by alkaline treatment. Additionally, in the case of peanut meal, extrusion alone leads to AF reduction by 23–66%, but coupled with ammonium hydroxide it can be up to 87%. Another heat treatment, roasting, leads to the reduction of AF amount in pecans and peanuts (50–70%) and maize (40–80%) [165].
Irradiation
Elimination of pathogenic organisms, and also, partially, AFs in food can be achieved by ionizing (gamma) or non-ionizing (solar, UV, microwave) radiation [165].
Compared with gamma-irradiation at 25 kGy (43% reduction) or microwave heating for 10 min (32% reduction), sunlight has been found to be more effective. Degradation of AFs by sunlight in cereals leads to reduction by 40% and up to 75% after 3 h and 30 h, respectively [179].
In other studies, gamma radiation has been used to irradiate maize, pistachio nuts, rice, and peanuts. The irradiation at 10 kGy induced 59–88% AF reduction. However, in another study, where irradiation at 15 kGy was employed, only 11–21% AF reduction has been proved [180,181].
The emission of UV-A (in dose 1200 mJ/cm2) has been shown to have a significant reduction effect on AFB1 and AFM1 in pure water by 70% and 84%, respectively. In cell culture studies, the increased dosage of UV- A emission has been shown to decreased or even suppress AF-induced cytotoxicity in HepG2 cells [182].
Pulsed Electric Fields
Due to AF thermostability, a pulsed electric fields (PEF) has been applied for its effective destruction. AFB1 and AF levels have been decreased by 77% and 97%, depending on the combination of different parameters as output voltage, pulse width, and pH, so the output voltage (20–65%), pH (4–10), and pulse width (10–26 µs), coupled with 2FI and quadratic models, result in PEF process optimization, which leads to AFB1 and total AF level reduction [183].
PEF treatment could be used for Aspergillus parasiticus inactivation and AF disintegration with alleviated mutagenic effects to preserve sesame seeds and their physicochemical properties. Levels of AFs B1, B2, G1, and G2, have been reduced by 86.9%, 98.7%, 94.7%, and, 92.7%, respectively with PEF energy in the range of 0.97 to 17.28 J, while the maximum PEF energy caused a 60% reduction of A. parasiticus [184].
5.2.2. Chemical Post-Harvest Methods
Chemical post-harvest methods for AF mitigation are based on intervention with chemical agents, e.g., adsorbents, acids, and bases.
Adsorbents
Clay-based adsorbents have been proposed for use as a new technique for removing AFs from contaminated liquids [185]. A potential adsorbent may be, inter alia, bentonite [186], which is listed by United States regulations as a safe ingredient that can be used as a direct food ingredient for human [187]. The effect of bentonite in reducing AFM1 in milk has been demonstrated by several studies. AFM1 reduction has been observed when bentonite was added directly to naturally contaminated milk [188,189]. However, bentonite, when added to feed for dairy cattle, has also been found to be effective in reducing AFM1 levels in milk indirectly [190,191] via adsorption of AFB1 in the gastrointestinal tract, leading to reducing its carry-over as AFM1 into milk [192].
Acids
Another type of AF treatment using strong acids has been proven to be effective for the conversion of AFB1 and AFG1 to their hemiacetal forms, demonstrated in the case of HCl (pH 2), which decreased AFB1 concentration by 19% in 24 h [188]. Among other tested acids, e.g., citric, acetic, and lactic acids under simulating cooking conditions, the last one turned out to be the most effective in transformation of AFB1 and AFB2 [193].
Bases
AFs are unstable under alkaline conditions. Ammonization can reduce AF concentration by more than 99%. AF degradation by ammonia has been widely studied and has been shown to be effective in both laboratory and field experiments [165,194].
5.2.3. Microbiological Post-Harvest Methods
Microbiological post-harvest methods for AF mitigation are based on intervention with microbiological agents as bacteria, and yeasts.
Bacteria
Lactic acid bacteria (e.g., Bifidobacterium animalis B subsp. lactis, Enterococcus avium, Lactobacillus acidophilus, L. selangorensis, Lactococcus lactis subsp. lactis, Pediococcus acidilactici, Streptococcus thermophilus, and Weissella confuse) have inhibitory effects on the AF production or cause the removal of AFs from foodstuffs and feedstuffs. The quality of AF binding by lactic acid bacteria strains depends on pH, temperature, the matrix itself, the incubation time, and also the inherent properties of the strain. AF elimination ranges for AFB1 from 16.3–98% and for AFM1 from 5.6–99.9%, and depends on the strain of lactic acid bacteria [163].
The degradation of AFs by probiotic bacteria to less or even non-toxic products has been shown to be an effective, safe, cheap, and environmentally friendly strategy of detoxification, with an approximately detoxification rate of 19–95% (for AFB1) and 12–100% (for AFM1) [106].
AF elimination by non-lactic acid bacteria (e.g., Bacillus licheniformis, Bacillus stearothermophilus, Bacillus subtilis, Brachybacterium spp., Brevundimonas spp., Cellulosimicrobium funkei, Enterobacter spp., Escherichia coli, Mycolicibacterium fluoranthenivorans, Mycolicibacterium smegmatis, Myxococcus fulvus, Nocardia corynebacterioides, Pseudomonas aeruginosa, Pseudomonas stutzeri, Rhodococcus erythropolis, Streptomyces aureofaciens, Streptomyces lividans, and Stenotrophomonas maltophilia) have an inhibitory effects on AF production or on the removal of AFs from milk at 4 °C. AF elimination ranges for AFB1 from 18–97% and for AFM1 from 32–64%, and depends on the strain of bacteria [163].
Yeast
In aflatoxigenic microfungi, the production of AFs has been significantly supressed by yeasts, e.g., Candida, Debaryomyces, Pichia, Saccharomyces, Saccharomycopsis, Saccharomycodes, Schizosaccharomyces, Aureobasidium pullulans, Trichosporon, and Zygosaccharomyces. AF elimination ranges for AFB1 from 15–100% and for AFM1 from 60–90.3%, and depends on the strain of yeasts [163].
It is known that yeast supplementation (e.g., Pichia kudriavzevii and Kluyveromyces marxianus) is able to detoxicate the AFB1 in rumina and reduce AFM1 levels in milk, which improves the dairy cattle performances [195].
5.2.4. Genetic Engineering Post-Harvest Methods
Firstly, genetic engineering technologies are based on the regulation mechanism of AF biosynthesis in A. flavus that lack the ability to produce AFs. Only precise genomic integration of mutant allele methods is required for accurate understanding of the mechanism for regulation of AF biosynthesis produced by A. flavus. The new strategy for the foreign DNA site-specific integration in the A. flavus sdh2 gene locus was evolved to prevent the disadvantage of ectopic or non-homologous recombination within integration of DNA into the genome [196].
Single substitution of amino acid (His 249 Leu) is involved in the mutant sdh2R allele on the pFC-eGFP vector, which has been established through cloning based on the yeast recombination for the transformation of fungi. A. flavus obtains systemic fungicide carboxin resistance as a result of a substitution of original sdh2 allele with sdh2R. Proper integration of the A. flavus NRRL 3357 genome into the locus sdh2 resulted in the highly efficient generation (>96%) of transformants [196]. The rapidity and effectiveness of this method consist of the locus sdh2 with inserted eGFP expression cassette, which leads to the alleviation of virulence and the growth of fungi. This process would be a helpful instrument for genetic manipulation of A. flavus [196].
On the other hand, genetic engineering technologies are based on transforming maize plants to a transgenic AF-free cultivar employing host-induced gene silencing [197]. The evolved transgenic maize with a hairpin construct focused on transcription factor aflR of the AF biosynthesis was exposed to an aflatoxigenic strain of A. flavus originating from an endemic AF outbreaks in eastern Kenya. The results demonstrated that A. flavus aflR transcription factor colonizing transgenic maize was downregulated. Besides, transgenic maize kernels concentrated 14-fold lower AF levels in comparison with wild maize kernels. In the transgenic maize, the silencing cassette induced reduced kernel placement and its stunting, which probable led to ‘‘off-target’’ silencing of unintended genes by aflR siRNAs in transformed plants [197].
Another study revealed that host-induced gene silencing significantly eliminates the AF toxin from transgenic maize. The maize plants were transformed by using the gene cassette, with the kernel-specific RNA interference (RNAi), targeting the aflC gene, encoding the enzyme at the Aspergillus biosynthetic pathway of the AFs. In these kernels of transgenic maize, AFs have not been detected, compared to non-transgenic maize kernels, in which the levels of AF were in thousands of ppb after pathogen infection. Meanwhile, the same similarity between transcript developing groups of transgenic and non-transgenic kernels has been observed. It was proved that small interfering RNA molecules could be employed in maize AF biosynthesis silence, which could lead to its use as an attractive strategy, and in the view of food safety improvement, may be implemented in other crops [198].
Finally, there are genetic engineering technologies based on transformed peanut with genetic A. flavus infection resistance and AF production using host-induced gene silencing.
In the case of peanuts, the significant resistance method could be used through biosynthetic AF pathway genes (aflM and aflP) by host-induced gene silencing and by overexpressed plant defensins MsDef1 and MtDef4.2 with antifungal ability. The first method, in the case of AF infection, suppresses AF production to provide permanent resistance against various morphotypes of A. flavus, which results in insignificant levels of AFs in peanuts; the second one improves A. flavus infection genetic resistance. The significant relation between the accumulation of AFs and biosynthetic AF pathway gene transcription decrease has been confirmed in the case of overexpressed defensins as well as in host-induced gene silencing lines [199].
6. Summary
In 2020, it was 60 years since the discovery of AFs, which are, among all mycotoxins, considered to be the most agriculturally important and harmful. Some toxic effects of AFs have been observed, including carcinogenicity. The numerous effective pre-harvest and post-harvest biocontrol methods for AF mitigation have been applied. Research focused on AF genetic variability and the diversity of A. flavus and other producers of AFs is very important and solves biocontrol strategy problematics of non-aflatoxigenic A. flavus strains with a view toward better public health protection and to prevent economic losses. At Present, biocontrol strategies are sufficient; however, they should be further improved due to developing knowledge about recombination using transgenic A. flavus strains and the use of genome editing methods. Future research should be focused on elaborating these novel biocontrol strategies and their wide testing possibilities in ordinary foodstuffs and feedstuffs.
Author Contributions
Conceptualization, V.O.; formal analysis, D.P.; investigation, V.O. and D.P.; resources, V.O. and J.T.; data curation, D.P., V.O., J.T., and F.M.; writing—original draft preparation, V.O.; writing—review and editing, D.P.; visualization, V.O.; supervision, V.O. and F.M.; project administration, V.O.; funding acquisition, D.P. and V.O. All authors have read and agreed to the published version of the manuscript.
Funding
Supported by the Ministry of Health, Czech Republic—conceptual development of research organization (“National Institute of Public Health-NIPH, IN 75010330“) and a specific research project (no. 2115/2020) of the Faculty of Science, University of Hradec Kralove, Czech Republic.
Institutional Review Board Statement
Not applicable.
Informed Consent Statement
Not applicable.
Data Availability Statement
Not applicable.
Acknowledgments
Dedicated to the memory of all researchers around the world who have substantially contributed to AF research and helped to build general knowledge on AFs.
Conflicts of Interest
The authors declare no conflict of interest.
References
- Benkerroum, N. Retrospective and Prospective Look at Aflatoxin Research and Development from a Practical Standpoint. Int. J. Environ. Res. Public Health 2019, 16, 3633. [Google Scholar] [CrossRef] [PubMed]
- Bennett, J.W.; Klich, M. Mycotoxins. Clin. Microbiol. Rev. 2003, 16, 497–516. [Google Scholar] [CrossRef] [PubMed]
- Bhat, R.; Rai, R.V.; Karim, A.A. Mycotoxins in Food and Feed: Present Status and Future Concerns. Compr. Rev. Food Sci. Food Saf. 2010, 9, 57–81. [Google Scholar] [CrossRef] [PubMed]
- Smith, J.S.; Paul Williams, W.; Windham, G.L. Aflatoxin in Maize: A Review of the Early Literature from “Moldy-Corn Toxicosis” to the Genetics of Aflatoxin Accumulation Resistance. Mycotoxin Res. 2019, 35, 111–128. [Google Scholar] [CrossRef]
- Blount, W.P. Turkey “X” Disease. J. Br. Turkey 1961, 9, 55–58. [Google Scholar]
- Wannop, C.C. Groundnut Toxicity in Poultry: Turkey X Disease. Br. Vet. J. 1963, 119, 174–177. [Google Scholar] [CrossRef]
- Siller, W.G.; Ostler, D.C. The Histopathology of an Enterohepatic Syndrome of Turkey Poults. Vet. Rec. 1961, 73, 134–138. [Google Scholar]
- Wannop, C.C. The Histopathology of Turkey “X” Disease in Great Britain. Avian. Dis. 1961, 5, 371–381. [Google Scholar] [CrossRef]
- Asplin, F.D.; Carnaghan, R.B.A. The Toxicity of Certain Groundnut Meals for Poultry with Special Reference to Their Effect on Ducklings and Chickens. Vet. Rec. 1961, 73, 1215–1219. [Google Scholar]
- Sargeant, K.; O’Kelly, J.; Carnaghan, R.B.A.; Allcroft, R. The Assay of a Toxic Principle in Certain Groundnut Meals. Vet. Rec. 1961, 73, 1219–1223. [Google Scholar]
- Sargeant, K.; Sheridan, A.; O’Kelly, J.; Carnaghan, R.B.A. Toxicity Associated with Certain Samples of Groundnuts. Nature 1961, 192, 1096–1097. [Google Scholar] [CrossRef]
- Loosmore, R.M.; Harding, J.D.J. A Toxic Factor in Brazilian Groundnut Causing Liver Damage in Pigs. Vet. Rec. 1961, 73, 1362–1364. [Google Scholar]
- Loosmore, R.M.; Markson, L.M. Poisoning of Cattle by Brazilian Groundnut Meal. Vet. Rec. 1961, 73, 813–814. [Google Scholar]
- Lancaster, M.C.; Jenkins, F.P.; Philp, J.M. Toxicity Associated with Certain Samples of Groundnuts. Nature 1961, 192, 1095–1096. [Google Scholar] [CrossRef]
- Schoental, R. Liver Changes and Primary Liver Tumours in Rats given Toxic Guinea Pig Diet (M.R.C. Diet 18). Br. J. Cancer 1961, 15, 812–815. [Google Scholar] [CrossRef] [PubMed]
- Allcroft, R.; Carnaghan, R.B.A. Toxic Products in Groundnuts. Biological Effects. Chem. Ind. 1963, 2, 50–53. [Google Scholar]
- Barnes, J.M.; Butler, W.H. Carcinogenic Activity of Aflatoxin to Rats. Nature 1964, 202, 1016. [Google Scholar] [CrossRef]
- Butler, W.H.; Barnes, J.M. Toxic Effects of Groundnut Meal Containing Aflatoxin to Rats and Guinea-Pigs. Br. J. Cancer 1963, 17, 699–710. [Google Scholar] [CrossRef] [PubMed]
- Le Breton, E.; Frayssient, C.; Boy, J. Sur l’apparition d’hépatomes “Spontanés” Chez Le Rat Wistar. Rôle de La Toxine d’Aspergillus Flavus. Intérêt En Pathologie Humaine et Cancérologie Expérimentale. C.R. Acad. Sci. 1962, 255, 784–786. [Google Scholar]
- Nesbitt, B.F.; O’Kelly, J.; Sargeant, K.; Sheridan, A.N.N. Aspergillus Flavus and Turkey X Disease. Toxic Metabolites of Aspergillus Flavus. Nature 1962, 195, 1062–1063. [Google Scholar] [CrossRef]
- Van der Zijden, A.S.M.; Koelensmid, W.; Boldingh, J.; Barrett, C.B.; Ord, W.O.; Philip, J. Aspergillus Flavus and Turkey X Disease: Isolation in Crystalline Form of a Toxin Responsible for Turkey X-Disease. Nature 1962, 195, 1060–1062. [Google Scholar] [CrossRef]
- Benkerroum, N. Aflatoxins: A Comprehensive Overview. Preprints 2019, 1–80. [Google Scholar] [CrossRef]
- Benkerroum, N. Aflatoxins: Producing-Molds, Structure, Health Issues and Incidence in Southeast Asian and Sub-Saharan African Countries. Int. J. Environ. Res. Public Health 2020, 17, 1215. [Google Scholar] [CrossRef] [PubMed]
- Fouché, T.; Claassens, S.; Maboeta, M. Aflatoxins in the Soil Ecosystem: An Overview of Its Occurrence, Fate, Effects and Future Perspectives. Mycotoxin Res. 2020, 36, 303–309. [Google Scholar] [CrossRef]
- Gnonlonfin, G.J.B.; Hell, K.; Adjovi, Y.; Fandohan, P.; Koudande, D.O.; Mensah, G.A.; Sanni, A.; Brimer, L. A Review on Aflatoxin Contamination and Its Implications in the Developing World: A Sub-Saharan African Perspective. Crit. Rev. Food Sci. Nutr. 2013, 53, 349–365. [Google Scholar] [CrossRef]
- Kensler, T.W.; Roebuck, B.D.; Wogan, G.N.; Groopman, J.D. Aflatoxin: A 50-Year Odyssey of Mechanistic and Translational Toxicology. Toxicol. Sci. 2011, 120, S28–S48. [Google Scholar] [CrossRef]
- Kumar, P.; Mahato, D.K.; Kamle, M.; Mohanta, T.K.; Kang, S.G. Aflatoxins: A Global Concern for Food Safety, Human Health and Their Management. Front. Microbiol. 2017, 7, 1–10. [Google Scholar] [CrossRef] [PubMed]
- Richard, J.L. Discovery of Aflatoxins and Significant Historical Features. Toxin Rev. 2008, 27, 171–201. [Google Scholar] [CrossRef]
- Rushing, B.R.; Selim, M.I. Aflatoxin B1: A Review on Metabolism, Toxicity, Occurrence in Food, Occupational Exposure, and Detoxification Methods. Food Chem. Toxicol. 2019, 124, 81–100. [Google Scholar] [CrossRef] [PubMed]
- Wild, C.P.; Gong, Y.Y. Mycotoxins and Human Disease: A Largely Ignored Global Health Issue. Carcinogenesis 2010, 31, 71–82. [Google Scholar] [CrossRef] [PubMed]
- Stevens, A.J.; Saunders, C.N.; Spence, J.B.; Newham, A.G. Investigations into” Diseases” of Turkey Poults. Vet. Rec. 1960, 72, 627–628. [Google Scholar]
- Blount, W.P. Disease of Turkey Poults. Vet. Rec. 1960, 72, 786. [Google Scholar]
- Blount, W.P. A New Turkey Disease Problem in England Characterised by Heavy Mortality. Br. Oil Cake Mills Ltd. Q. Poult. Bull. 1960, 27, 1–3. [Google Scholar]
- Van Dorp, D.A.; van Der Zijden, A.S.M.; Beerthuis, R.K.; Sparreboom, S.; Ord, W.O.; De Jong, K.; Keuning, R. Dihydro-Aflatoxin B, a Metabolite of Aspergillus Flavus. Remarks on the Structure of Aflatoxin B. Recl. Trav. Chim. Pays-Bas 1963, 82, 587–592. [Google Scholar] [CrossRef]
- Smith, R.H.; McKernan, W. Hepatotoxic Action of Chromatographically Separated Fractions of Aspergillus Flavus Extracts. Nature 1962, 195, 1301–1303. [Google Scholar] [CrossRef]
- De Iongh, H.; Beerthuis, R.K.; Vles, R.O.; Barrett, C.B.; Ord, W.O. Investigation of the Factor in Groundnut Meal Responsible for “Turkey X Disease”. Biochim. Biophys. Acta 1962, 65, 548–551. [Google Scholar] [CrossRef]
- Allcroft, R.; Carnaghan, R.B.A. Groundnut Toxicity. Aspergillus Flavus Toxin (Aflatoxin) in Animal Products: Preliminary Communication. Vet. Rec. 1962, 74, 863–864. [Google Scholar]
- Asao, T.; Buchi, G.; Abdel-Kader, M.M.; Chang, S.B.; Wick, E.L.; Wogan, G.N. Aflatoxins B and G. J. Am. Chem. Soc. 1963, 85, 1706–1707. [Google Scholar] [CrossRef]
- Austwick, P.K.C.; Ayerst, G. Toxic Products in Groundnuts: Groundnut Microflora and Toxicity. Chem. Ind. 1963, 55–61. [Google Scholar]
- Sargkant, K.; Carnaghan, R.B.A.; Allcroft, R. Toxic Products in Groundnuts. Chemistry and Origin. Chem. Ind. 1963, 2, 50–53. [Google Scholar]
- Raper, K.B.; Fennel, D.I. The Genus Aspergillus; Williams and Wilkins: Baltimore, MD, USA, 1965. [Google Scholar]
- Zhang, K.; Wong, J.W.; Krynitsky, A.J.; Trucksess, M.W. Perspective on Advancing FDA Regulatory Monitoring for Mycotoxins in Foods Using Liquid Chromatography and Mass Spectrometry (Review). J. AOAC Int. 2016, 99, 890–894. [Google Scholar] [CrossRef]
- De Iongh, H.; Vles, R.O.; Van Pelt, J.G. Milk of Mammals Fed an Aflatoxin-Containing Diet. Nature 1964, 202, 466–467. [Google Scholar] [CrossRef]
- Payet, M.; Cros, J.; Quenum, C.; Sankale, M.; Moulanier, M. Deux Observations d’enfants Ayant Consommé de Façon Prolongée Des Farines Souillées Par Aspergillus Flavus. Presse Med. 1966, 74, 649–651. [Google Scholar]
- Holzapfel, C.W.; Steyn, P.S.; Purchase, I.F. Isolation and Structure of Aflatoxins M1 and M2. Tetrahedron Lett. 1966, 25, 2799–2803. [Google Scholar] [CrossRef]
- Allcroft, R.; Rogers, H.; Lewis, G.; Nabney, J.; Best, P.E. Metabolism of Aflatoxin in Sheep: Excretion of the ‘Milk Toxin’. Nature 1966, 209, 154–155. [Google Scholar] [CrossRef] [PubMed]
- Buechi, G.; Foulkes, D.M.; Kurono, M.; Mitchell, G.F.; Schneider, R.S. Total Synthesis of Racemic Aflatoxin B1. J. Am. Chem. Soc. 1967, 89, 6745–6753. [Google Scholar] [CrossRef]
- Serck-Hanssen, A. Aflatoxin-Induced Fatal Hepatitis? A Case Report from Uganda. Arch. Environ. Health 1970, 20, 729–731. [Google Scholar] [CrossRef] [PubMed]
- IARC Aflatoxins. IARC Monographs on Evaluation of Carcinogenic Risk of Chemicals to Man; IARC Press: Lyon, France, 1972; pp. 145–156. [Google Scholar]
- Krishnamachari, K.A.; Bhat, R.V.; Nagarajan, V.; Tilak, T.B. Hepatitis Due to Aflatoxicosis. An Outbreak in Western India. Lancet 1975, 305, 1061–1063. [Google Scholar] [CrossRef]
- IARC Aflatoxins. IARC Monographs on the Evaluation of the Crcinogenic Risk of Chemicals to Man: Some Naturally Occurring Substances; IARC Press: Lyon, France, 1976; pp. 51–72. [Google Scholar]
- FDA—US Food and Drug Administration. CPG Sec. 527.400 Whole Milk, Lowfat Milk, Skim Milk—Aflatoxin M1. Available online: https://www.fda.gov/regulatory-information/search-fda-guidance-documents/cpg-sec-527400-whole-milk-lowfat-milk-skim-milk-aflatoxin-m1 (accessed on 9 February 2020).
- Essigmann, J.M.; Croy, R.G.; Nadzan, A.M.; Busby, W.F.; Reinhold, V.N.; Büchi, G.; Wogan, G.N. Structural Identification of the Major DNA Adduct Formed by Aflatoxin B1 in Vitro. Proc. Natl. Acad. Sci. USA 1977, 74, 1870–1874. [Google Scholar] [CrossRef] [PubMed]
- FAO. Perspective on Mycotoxins. In Selected Documents of the Joint FAO/WHO/UNEP, Proceedings of the Conference on Mycotoxins, Nairobi, Kenya, 19–27 September 1977; FAO Food and Nutrition Paper; FAO: Nairobi, Kenya, 1979; Volume 13, pp. 1–167. [Google Scholar]
- Goto, T.; Manabe, M.; Matsuura, S. Application of High-Performance Liquid Chromatography to the Analysis of Aflatoxins in Foods and Feeds. Preparation of Sample and Column. Agric. Biol. Chem. 1979, 43, 2591–2592. [Google Scholar] [CrossRef]
- Bennett, R.A.; Essigmann, J.M.; Wogan, G.N. Excretion of an Aflatoxin-Guanine Adduct in the Urine of Aflatoxin B1-Treated Rats. Cancer Res. 1981, 41, 650–654. [Google Scholar]
- Sorenson, W.G.; Jones, W.; Simpson, J.; Davidson, J.I. Aflatoxin in Respirable Airborne Peanut Dust. J. Toxicol. Environ. Health 1984, 14, 525–533. [Google Scholar] [CrossRef]
- Woychik, N.A.; Hinsdill, R.D.; Chu, F.S. Production and Characterization of Monoclonal Antibodies against Aflatoxin M1. Appl. Environ. Microbiol. 1984, 48, 1096–1099. [Google Scholar] [CrossRef] [PubMed]
- IARC Aflatoxins. IARC Monographs on the Evaluation of the Carcinogenic Risks to Humans. Overall Evaluations of Carcinogenicity: An Updating of IARC Monographs; IARC Monographs Supplement 7; International Agency for Research in Cancer: Lyon, France, 1987; Volume 1–42, pp. 83–87. ISBN 92 832 1411 0. [Google Scholar]
- Kurtzman, C.P.; Horn, B.W.; Hesseltine, C.W. Aspergillus Nomius, a New Aflatoxin-Producing Species Related to Aspergillus Flavus and Aspergillus Tamarii. Antonie Van Leeuwenhoek 1987, 53, 147–158. [Google Scholar] [CrossRef] [PubMed]
- Sabbioni, G.; Skipper, P.L.; Büchi, G.; Tannenbaum, S.R. Isolation and Characterization of the Major Serum Albumin Adduct Formed by Aflatoxin B1 in Vivo in Rats. Carcinogenesis 1987, 8, 819–824. [Google Scholar] [CrossRef]
- Bosch, F.X.; Muñoz, N. Prospects for Epidemiological Studies on Hepatocellular Cancer as a Model for Assessing Viral and Chemical Interactions. IARC Sci. Publ. 1988, 89, 427–438. [Google Scholar]
- Groopman, J.D.; Hall, A.J.; Whittle, H.; Hudson, G.J.; Wogan, G.N.; Montesano, R.; Wild, C.P. Molecular Dosimetry of Aflatoxin-N7-Guanine in Human Urine Obtained in The Gambia, West Africa. Cancer Epidemiol. Biomark. Prev. 1992, 1, 221–227. [Google Scholar]
- Groopman, J.D.; Zhu, J.Q.; Donahue, P.R.; Pikul, A.; Zhang, L.S.; Chen, J.S.; Wogan, G.N. Molecular Dosimetry of Urinary Aflatoxin-DNA Adducts in People Living in Guangxi Autonomous Region, People’s Republic of China. Cancer Res. 1992, 52, 45–52. [Google Scholar]
- Gan, L.S.; Skipper, P.L.; Peng, X.C.; Groopman, J.D.; Chen, J.S.; Wogan, G.N.; Tannenbaum, S.R. Serum Albumin Adducts in the Molecular Epidemiology of Aflatoxin Carcinogenesis: Correlation with Aflatoxin B1 Intake and Urinary Excretion of Aflatoxin M1. Carcinogenesis 1988, 9, 1323–1325. [Google Scholar] [CrossRef] [PubMed]
- Bressac, B.; Kew, M.; Wands, J.; Ozturk, M. Selective G to T Mutations of P53 Gene in Hepatocellular Carcinoma from Southern Africa. Nature 1991, 350, 429–431. [Google Scholar] [CrossRef] [PubMed]
- Yabe, K.; Ando, Y.; Hamasaki, T. A Metabolic Grid among Versiconal Hemiacetal Acetate, Versiconol Acetate, Versiconol and Versiconal during Aflatoxin Biosynthesis. J. Gen. Microbiol. 1991, 137, 2469–2475. [Google Scholar] [CrossRef]
- Ross, R.K.; Yuan, J.M.; Yu, M.C.; Wogan, G.N.; Qian, G.S.; Tu, J.T.; Groopman, J.D.; Gao, Y.T.; Henderson, B.E. Urinary Aflatoxin Biomarkers and Risk of Hepatocellular Carcinoma. Lancet 1992, 339, 943–946. [Google Scholar] [CrossRef]
- IARC International Agency for Research on Cancer. IARC Monographs on the Evaluation of Carcinogenic Risks to Humans: Some Naturally Occuring Substances: Food Items and Costituents, Heterocyclic Aromatic Amines and Mycotoxins; IARC Press: Lyon, France, 1993; Volume 56, ISBN 92-832-1256-8. [Google Scholar]
- Shapira, R.; Paster, N.; Eyal, O.; Menasherov, M.; Mett, A.; Salomon, R. Detection of Aflatoxigenic Molds in Grains by PCR. Appl. Environ. Microbiol. 1996, 62, 3270–3273. [Google Scholar] [CrossRef]
- Lasky, T.; Magder, L. Hepatocellular Carcinoma P53 G > T Transversions at Codon 249: The Fingerprint of Aflatoxin Exposure? Environ. Health Perspect. 1997, 105, 392–397. [Google Scholar] [CrossRef]
- Geiser, D.M.; Pitt, J.I.; Taylor, J.W. Cryptic Speciation and Recombination in the Aflatoxin-Producing Fungus Aspergillus Flavus. Proc. Natl. Acad. Sci. USA 1998, 95, 388–393. [Google Scholar] [CrossRef]
- Vahl, M.; Jørgensen, K. Determination of Aflatoxins in Food Using LC/MS/MS. Z. Lebensm. Unters. Forsch. 1998, 206, 243–245. [Google Scholar] [CrossRef]
- European Commission. Commission Regulation (EC) No 466/2001 of 8 March 2001 Setting Maximum Levels for Certain Contaminants in Foodstuffs (Text with EEA Relevance). Off. J. Eur. Comm. 2001, 1–13. [Google Scholar]
- International Agency for Research on Cancer. IARC Monographs on the Evaluation of Carcinogenic Risks to Humans: Some Traditional Herbal Medicine, Some Mycotoxins, Naphthalene and Strene; IARC Press: Lyon, France, 2002; Volume 82, ISBN 92-832-1282-7. [Google Scholar]
- European Commission. Commission Regulation (EC) No 2174/2003 of 12 December 2003 Amending Regulation (EC) No 466/2001 as Regards Aflatoxins (Text with EEA Relevance). Off. J. Eur. Union 2003, 326, 12–15. [Google Scholar]
- Azziz-Baumgartner, E.; Lindblade, K.; Gieseker, K.; Rogers, H.S.; Kieszak, S.; Njapau, H.; Schleicher, R.; McCoy, L.F.; Misore, A.; DeCock, K.; et al. Case-Control Study of an Acute Aflatoxicosis Outbreak, Kenya, 2004. Environ. Health Perspect. 2005, 113, 1779–1783. [Google Scholar] [CrossRef]
- Yu, J.; Chang, P.-K.; Ehrlich, K.C.; Cary, J.W.; Bhatnagar, D.; Cleveland, T.E.; Payne, G.A.; Linz, J.E.; Woloshuk, C.P.; Bennett, J.W. Clustered Pathway Genes in Aflatoxin Biosynthesis. Appl. Environ. Microbiol. 2004, 70, 1253–1262. [Google Scholar] [CrossRef] [PubMed]
- European Commission. Commision Regulation (EC) No 401/2006 of 23 February 2006 Lying down the Methods of Sampling and Analysis for the Official Control of the Levels of Mycotoxins in Foodstuffs. Off. J. Eur. Union 2006, 70, 12–34. [Google Scholar]
- European Commission. Commission Regulation (EC) No. 1881/2006 of 19 December 2006 Setting Maximum Levels for Certain Contaminants in Foodstuffs. Off. J. Eur. Union 2006, 364, 5–24. [Google Scholar]
- Yard, E.E.; Daniel, J.H.; Lewis, L.S.; Rybak, M.E.; Paliakov, E.M.; Kim, A.A.; Montgomery, J.M.; Bunnell, R.; Abudo, M.U.; Akhwale, W.; et al. Human Aflatoxin Exposure in Kenya, 2007: A Cross-Sectional Study. Food Addit. Contam. Part A 2013, 30, 1322–1331. [Google Scholar] [CrossRef] [PubMed]
- Bandyopadhyay, R.; Atehnkeng, J.; Ortega-Beltran, A.; Akande, A.; Falade, T.D.O.; Cotty, P.J. “Ground-Truthing” Efficacy of Biological Control for Aflatoxin Mitigation in Farmers’ Fields in Nigeria: From Field Trials to Commercial Usage, a 10-Year Study. Front. Microbiol. 2019, 10, 1–18. [Google Scholar] [CrossRef] [PubMed]
- Battilani, P.; Rossi, V.; Giorni, P.; Pietri, A.; Gualla, A.; Van der Fels-Klerx, H.J.; Booij, C.J.H.; Moretti, A.; Logrieco, A.; Miglietta, F. Modelling, Predicting and Mapping the Emergence of Aflatoxins in Cereals in the EU Due to Climate Change. EFSA Support. Publ. 2012, 9, 1–172. [Google Scholar] [CrossRef]
- International Agency for Research on Cancer. Aflatoxins. In Chemical Agents and Related Occupations: A Review of Human Carcinogens; IARC Press: Lyon, France, 2012; Volume 100F, pp. 225–248. ISBN 978 92 832 1323 9. [Google Scholar]
- Duarte, S.C.; Almeida, A.M.; Teixeira, A.S.; Pereira, A.L.; Falcão, A.C.; Pena, A.; Lino, C.M. Aflatoxin M1 in Marketed Milk in Portugal: Assessment of Human and Animal Exposure. Food Control 2013, 30, 411–417. [Google Scholar] [CrossRef]
- Tsakiris, I.N.; Tzatzarakis, M.N.; Alegakis, A.K.; Vlachou, M.I.; Renieri, E.A.; Tsatsakis, A.M. Risk Assessment Scenarios of Children’s Exposure to Aflatoxin M1 Residues in Different Milk Types from the Greek Market. Food Chem. Toxicol. 2013, 56, 261–265. [Google Scholar] [CrossRef]
- Santini, A.; Raiola, A.; Ferrantelli, V.; Giangrosso, G.; Macaluso, A.; Bognanno, M.; Galvano, F.; Ritieni, A. Aflatoxin M1 in Raw, UHT Milk and Dairy Products in Sicily (Italy). Food Addit. Contam. Part B 2013, 6, 181–186. [Google Scholar] [CrossRef] [PubMed]
- European Food Safety Authority. Effect on Public Health of a Possible Increase of the Maximum Level for ‘Aflatoxin Total’ from 4 to 10 Μg/Kg in Peanuts and Processed Products Thereof, Intended for Direct Human Consumption or Use as an Ingredient in Foodstuffs. EFSA J. 2018, 16, 1–32. [Google Scholar] [CrossRef]
- Herrman, T.J.; Hoffman, V.; Muiruri, A.; McCormick, C. Aflatoxin Proficiency Testing and Control in Kenya. J. Food Prot. 2019, 83, 142–146. [Google Scholar] [CrossRef] [PubMed]
- Frisvad, J.C.; Hubka, V.; Ezekiel, C.N.; Hong, S.-B.; Nováková, A.; Chen, A.J.; Arzanlou, M.; Larsen, T.O.; Sklenář, F.; Mahakarnchanakul, W.; et al. Taxonomy of Aspergillus Section Flavi and Their Production of Aflatoxins, Ochratoxins and Other Mycotoxins. Stud. Mycol. 2019, 93, 1–63. [Google Scholar] [CrossRef] [PubMed]
- European Food Safety Authority. Risk Assessment of Aflatoxins in Food. EFSA J. 2020, 18, 1–112. [Google Scholar] [CrossRef]
- Singh, P.; Orbach, M.J.; Cotty, P.J. Aspergillus Texensis: A Novel Aflatoxin Producer with S Morphology from the United States. Toxins 2018, 10, 513. [Google Scholar] [CrossRef] [PubMed]
- Singh, P.; Callicott, K.A.; Orbach, M.J.; Cotty, P.J. Molecular Analysis of S-Morphology Aflatoxin Producers from the United States Reveals Previously Unknown Diversity and Two New Taxa. Front. Microbiol. 2020, 11, 1–16. [Google Scholar] [CrossRef] [PubMed]
- Liu, W.; Wang, L.; Yang, X.; Zeng, H.; Zhang, R.; Pu, C.; Zheng, C.; Tan, Y.; Luo, Y.; Feng, X.; et al. Environmental Microcystin Exposure Increases Liver Injury Risk Induced by Hepatitis B Virus Combined with Aflatoxin: A Cross-Sectional Study in Southwest China. Environ. Sci. Technol. 2017, 51, 6367–6378. [Google Scholar] [CrossRef]
- Guo, H.; Ji, J.; Wang, J.; Sun, X. Co-Contamination and Interaction of Fungal Toxins and Other Environmental Toxins. Trends Food Sci. Technol. 2020, 103, 162–178. [Google Scholar] [CrossRef]
- Renu, K.; Chakraborty, R.; Myakala, H.; Koti, R.; Famurewa, A.C.; Madhyastha, H.; Vellingiri, B.; George, A.; Valsala Gopalakrishnan, A. Molecular Mechanism of Heavy Metals (Lead, Chromium, Arsenic, Mercury, Nickel and Cadmium)—Induced Hepatotoxicity—A Review. Chemosphere 2021, 271, 129735. [Google Scholar] [CrossRef]
- Guan, Y.; Chen, J.; Nepovimova, E.; Long, M.; Wu, W.; Kuca, K. Aflatoxin Detoxification Using Microorganisms and Enzymes. Toxins 2021, 13, 46. [Google Scholar] [CrossRef]
- Sipos, P.; Peles, F.; Brassó, D.L.; Béri, B.; Pusztahelyi, T.; Pócsi, I.; Győri, Z. Physical and Chemical Methods for Reduction in Aflatoxin Content of Feed and Food. Toxins 2021, 13, 204. [Google Scholar] [CrossRef]
- Fan, T.; Xie, Y.; Ma, W. Research Progress on the Protection and Detoxification of Phytochemicals against Aflatoxin B1-Induced Liver Toxicity. Toxicon 2021, 195, 58–68. [Google Scholar] [CrossRef]
- Hamid, A.S.; Tesfamariam, I.G.; Zhang, Y.; Zhang, Z.G. Aflatoxin B1-Induced Hepatocellular Carcinoma in Developing Countries: Geographical Distribution, Mechanism of Action and Prevention (Review). Oncol. Lett. 2013, 5, 1087–1092. [Google Scholar] [CrossRef] [PubMed]
- Williams, J.H.; Phillips, T.D.; Jolly, P.E.; Stiles, J.K.; Jolly, C.M.; Aggarwal, D. Human Aflatoxicosis in Developing Countries: A Review of Toxicology, Exposure, Potential Health Consequences, and Interventions. Am. J. Clin. Nutr. 2004, 80, 1106–1122. [Google Scholar] [CrossRef] [PubMed]
- Singh, U.; Gupta, S.; Gupta, M. A Review on Study on Biological Ill Effects and Health Hazards f Aflatoxins. Int. J. Adv. Med. 2021, 3, 1–8. [Google Scholar]
- Pickova, D.; Ostry, V.; Malir, F. A Recent Overview of Producers and Important Dietary Sources of Aflatoxins. Toxins 2021, 13, 186. [Google Scholar] [CrossRef] [PubMed]
- World Health Organization. Aflatoxins. Available online: https://www.who.int/foodsafety/FSDigest_Aflatoxins_EN.pdf (accessed on 9 February 2020).
- Ostry, V.; Malir, F.; Toman, J.; Grosse, Y. Mycotoxins as Human Carcinogens—The IARC Monographs Classification. Mycotoxin Res. 2017, 33, 65–73. [Google Scholar] [CrossRef]
- Afshar, P.; Shokrzadeh, M.; Raeisi, S.N.; Ghorbani-HasanSaraei, A.; Nasiraii, L.R. Aflatoxins Biodetoxification Strategies Based on Probiotic Bacteria. Toxicon 2020, 178, 50–58. [Google Scholar] [CrossRef]
- Benkerroum, N. Chronic and Acute Toxicities of Aflatoxins: Mechanisms of Action. Int. J. Environ. Res. Public Health 2020, 17, 423. [Google Scholar] [CrossRef]
- Hua, Z.; Liu, R.; Chen, Y.; Liu, G.; Li, C.; Song, Y.; Cao, Z.; Li, W.; Li, W.; Lu, C.; et al. Contamination of Aflatoxins Induces Severe Hepatotoxicity Through Multiple Mechanisms. Front. Pharmacol. 2020, 11, 605823. [Google Scholar] [CrossRef]
- Pickova, D.; Ostry, V.; Malir, J.; Toman, J.; Malir, F. A Review on Mycotoxins and Microfungi in Spices in the Light of the Last Five Years. Toxins 2020, 12, 789. [Google Scholar] [CrossRef] [PubMed]
- Zhou, H.; Wang, J.; Ma, L.; Chen, L.; Guo, T.; Zhang, Y.; Dai, H.; Yu, Y. Oxidative DNA Damage and Multi-Organ Pathologies in Male Mice Subchronically Treated with Aflatoxin B1. Ecotoxicol. Environ. Saf. 2019, 186, 1–10. [Google Scholar] [CrossRef] [PubMed]
- Li, X.; Lv, Z.; Chen, J.; Nepovimova, E.; Long, M.; Wu, W.; Kuca, K. Bacillus Amyloliquefaciens B10 Can Alleviate Liver Apoptosis and Oxidative Stress Induced by Aflatoxin B1. Food Chem. Toxicol. 2021, 151, 112124. [Google Scholar] [CrossRef]
- Owumi, S.; Najophe, E.S.; Farombi, E.O.; Oyelere, A.K. Gallic Acid Protects against Aflatoxin B1-Induced Oxidative and Inflammatory Stress Damage in Rats Kidneys and Liver. J. Food Biochem. 2020, 44, 13316. [Google Scholar] [CrossRef]
- Hassan, A.A.; Abu Hafsa, S.H.; Elghandour, M.M.M.Y.; Kanth Reddy, P.R.; Monroy, J.C.; Salem, A.Z.M. Dietary Supplementation with Sodium Bentonite and Coumarin Alleviates the Toxicity of Aflatoxin B1 in Rabbits. Toxicon 2019, 171, 35–42. [Google Scholar] [CrossRef]
- Śliżewska, K.; Cukrowska, B.; Smulikowska, S.; Cielecka-Kuszyk, J. The Effect of Probiotic Supplementation on Performance and the Histopathological Changes in Liver and Kidneys in Broiler Chickens Fed Diets with Aflatoxin B1. Toxins 2019, 11, 112. [Google Scholar] [CrossRef] [PubMed]
- Park, S.; Lee, J.-Y.; You, S.; Song, G.; Lim, W. Neurotoxic Effects of Aflatoxin B1 on Human Astrocytes in Vitro and on Glial Cell Development in Zebrafish in Vivo. J. Hazard. Mater. 2020, 386, 121639. [Google Scholar] [CrossRef]
- Pang, V.F.; Chiang, C.-F.; Chang, C.-C. The in Vitro Effects of Aflatoxin B1 on Physiological Functions of Swine Alveolar Macrophages. Vet. Med. Sci. 2020, 6, 919–925. [Google Scholar] [CrossRef] [PubMed]
- El-Sayed Mostafa, H.; Ahmed Allithy, A.N.; Abdellatif, N.A.; Anani, M.; Fareed, S.A.; El-Shafei, D.A.; Alaa El-Din, E.A. Amelioration of Pulmonary Aflatoxicosis by Green Tea Extract: An in Vivo Study. Toxicon 2021, 189, 48–55. [Google Scholar] [CrossRef] [PubMed]
- Akinrinde, A.S.; Adebiyi, O.E.; Asekun, A. Amelioration of Aflatoxin B1-Induced Gastrointestinal Injuries by Eucalyptus Oil in Rats. J. Complement. Integr. Med. 2019, 17, 1–11. [Google Scholar] [CrossRef]
- Pu, J.; Yuan, Q.; Yan, H.; Tian, G.; Chen, D.; He, J.; Zheng, P.; Yu, J.; Mao, X.; Huang, Z.; et al. Effects of Chronic Exposure to Low Levels of Dietary Aflatoxin B1 on Growth Performance, Apparent Total Tract Digestibility and Intestinal Health in Pigs. Animals 2021, 11, 336. [Google Scholar] [CrossRef] [PubMed]
- Hernández-Ramírez, J.O.; Nava-Ramírez, M.J.; Merino-Guzmán, R.; Téllez-Isaías, G.; Vázquez-Durán, A.; Méndez-Albores, A. The Effect of Moderate-Dose Aflatoxin B1 and Salmonella Enteritidis Infection on Intestinal Permeability in Broiler Chickens. Mycotoxin Res. 2020, 36, 31–39. [Google Scholar] [CrossRef] [PubMed]
- Choi, S.-Y.; Kim, T.H.; Hong, M.-W.; Park, T.S.; Lee, H.; Lee, S.-J. Transcriptomic Alterations Induced by Aflatoxin B1 and Ochratoxin A in LMH Cell Line. Poult. Sci. 2020, 99, 5265–5274. [Google Scholar] [CrossRef]
- Tadee, A.; Mahakunakorn, P.; Porasuphatana, S. Oxidative Stress and Genotoxicity of Co-Exposure to Chlorpyrifos and Aflatoxin B1 in HepG2 Cells. Toxicol. Ind. Health 2020, 36, 336–345. [Google Scholar] [CrossRef] [PubMed]
- Wang, X.; Li, L.; Zhang, G. Quercetin Protects the Buffalo Rat Liver (BRL-3A) Cells from Aflatoxin B1-Induced Cytotoxicity via Activation of Nrf2-ARE Pathway. World Mycotoxin J. 2020, 13, 299–312. [Google Scholar] [CrossRef]
- Wu, K.; Jia, S.; Zhang, J.; Zhang, C.; Wang, S.; Rajput, S.A.; Sun, L.; Qi, D. Transcriptomics and Flow Cytometry Reveals the Cytotoxicity of Aflatoxin B1 and Aflatoxin M1 in Bovine Mammary Epithelial Cells. Ecotoxicol. Environ. Saf. 2021, 209, 1–9. [Google Scholar] [CrossRef] [PubMed]
- Dey, D.K.; Kang, S.C. Aflatoxin B1 Induces Reactive Oxygen Species-Dependent Caspase-Mediated Apoptosis in Normal Human Cells, Inhibits Allium Cepa Root Cell Division, and Triggers Inflammatory Response in Zebrafish Larvae. Sci. Total Environ. 2020, 737, 139704. [Google Scholar] [CrossRef]
- Jiang, Y.; Hansen, P.J.; Xiao, Y.; Amaral, T.F.; Vyas, D.; Adesogan, A.T. Aflatoxin Compromises Development of the Preimplantation Bovine Embryo through Mechanisms Independent of Reactive Oxygen Production. J. Dairy Sci. 2019, 102, 10506–10513. [Google Scholar] [CrossRef] [PubMed]
- Milićević, D.R.; Škrinjar, M.; Baltić, T. Real and Perceived Risks for Mycotoxin Contamination in Foods and Feeds: Challenges for Food Safety Control. Toxins 2010, 2, 572. [Google Scholar] [CrossRef]
- Grenier, B.; Oswald, I. Mycotoxin Co-contamination of Food and Feed: Meta-Analysis of Publications Describing Toxicological Interactions. World Mycotoxin J. 2011, 4, 285–313. [Google Scholar] [CrossRef]
- Streit, E.; Naehrer, K.; Rodrigues, I.; Schatzmayr, G. Mycotoxin Occurrence in Feed and Feed Raw Materials Worldwide -Long Term Analysis with Special Focus on Europe and Asia. J. Sci. Food Agric. 2013, 93, 2892–2899. [Google Scholar] [CrossRef]
- Smith, M.-C.; Madec, S.; Coton, E.; Hymery, N. Natural Co-occurrence of Mycotoxins in Foods and Feeds and Their in Vitro Combined Toxicological Effects. Toxins 2016, 8, 94. [Google Scholar] [CrossRef]
- Huang, S.; Zheng, N.; Fan, C.; Cheng, M.; Wang, S.; Jabar, A.; Wang, J.; Cheng, J. Effects of Aflatoxin B1 Combined with Ochratoxin A and/or Zearalenone on Metabolism, Immune Function, and Antioxidant Status in Lactating Dairy Goats. Asian Australas. J. Anim. Sci. 2018, 31, 505–513. [Google Scholar] [CrossRef]
- Hou, L.; Gan, F.; Zhou, X.; Zhou, Y.; Qian, G.; Liu, Z.; Huang, K. Immunotoxicity of Ochratoxin A and Aflatoxin B1 in Combination Is Associated with the Nuclear Factor Kappa B Signaling Pathway in 3D4/21 cells. Chemosphere 2018, 199, 718–727. [Google Scholar] [CrossRef]
- Ji, J.; Wang, Q.; Wu, H.; Xia, S.; Guo, H.; Blaženović, I.; Zhang, Y.; Sun, X. Insights into Cellular Metabolic Pathways of the Combined Toxicity Responses of Caco-2 Cells Exposed to Deoxynivalenol, Zearalenone and Aflatoxin B1. Food Chem. Toxicol. 2019, 126, 106–112. [Google Scholar] [CrossRef] [PubMed]
- Eze, U.A.; Huntriss, J.; Routledge, M.N.; Gong, Y.Y. Toxicological Effects of Regulated Mycotoxins and Persistent Organochloride Pesticides: In Vitro Cytotoxic Assessment of Single and Defined Mixtures on MA-10 Murine Leydig Cell Line. Toxicol. In Vitro 2018, 48, 93–103. [Google Scholar] [CrossRef]
- Gao, Y.; Bao, X.; Meng, L.; Liu, H.; Wang, J.; Zheng, N. Aflatoxin B1 and Aflatoxin M1 Induce Compromised Intestinal Integrity through Clathrin-Mediated Endocytosis. Toxins 2021, 13, 184. [Google Scholar] [CrossRef]
- Zhao, Q.; Yang, Z.-S.; Cao, S.-J.; Chang, Y.-F.; Cao, Y.-Q.; Li, J.-B.; Yao, Z.-X.; Wen, Y.-P.; Huang, X.-B.; Wu, R.; et al. Acute Oral Toxicity Test and Assessment of Combined Toxicity of Cadmium and Aflatoxin B1 in Kunming Mice. Food Chem. Toxicol. 2019, 131, 1–7. [Google Scholar] [CrossRef]
- Olugbami, J.O.; Damoiseaux, R.; Odunola, O.A.; Gimzewski, J.K. Mitigation of Aflatoxin B1- and Sodium Arsenite-Induced Cytotoxicities in HUC-PC Urinary Bladder Cells by Curcumin and Khaya Senegalensis. J. Basic Clin. Physiol. Parmacol. 2020, 31. [Google Scholar] [CrossRef] [PubMed]
- Liu, W.; Wang, L.; Zheng, C.; Liu, L.; Wang, J.; Li, D.; Tan, Y.; Zhao, X.; He, L.; Shu, W. Microcystin-LR Increases Genotoxicity Induced by Aflatoxin B1 through Oxidative Stress and DNA Base Excision Repair Genes in Human Hepatic Cell Lines. Environ. Pollut. 2018, 233, 455–463. [Google Scholar] [CrossRef]
- Wang, L.; He, L.; Zeng, H.; Fu, W.; Wang, J.; Tan, Y.; Zheng, C.; Qiu, Z.; Luo, J.; Lv, C.; et al. Low-Dose Microcystin-LR Antagonizes Aflatoxin B1 Induced Hepatocarcinogenesis through Decreasing Cytochrome P450 1A2 Expression and Aflatoxin B1-DNA Adduct Generation. Chemosphere 2020, 248, 126036. [Google Scholar] [CrossRef]
- Meneely, J.P.; Hajšlová, J.; Krska, R.; Elliott, C.T. Assessing the Combined Toxicity of the Natural Toxins, Aflatoxin B1, Fumonisin B1 and Microcystin-LR by High Content Analysis. Food Chem. Toxicol. 2018, 121, 527–540. [Google Scholar] [CrossRef] [PubMed]
- Chen, Y.; Liu, Y. Non-Coplanar and Coplanar Polychlorinated Biphenyls Potentiate Genotoxicity of Aflatoxin B1 in a Human Hepatocyte Line by Enhancing CYP1A2 and CYP3A4 Expression. Environ. Pollut. 2019, 246, 945–954. [Google Scholar] [CrossRef]
- Fishbein, A.; Hammock, B.D.; Serhan, C.N.; Panigrahy, D. Carcinogenesis: Failure of Resolution of Inflammation? Pharmacol. Ther. 2021, 218, 107670. [Google Scholar] [CrossRef]
- Peraica, M.; Radić, B.; Lucić, A.; Pavlović, M. Toxic Effects of Mycotoxins in Human. Bull. World Health Organ. 1999, 77, 754–766. [Google Scholar] [PubMed]
- Ismail, A.; Gonçalves, B.L.; de Neeff, D.V.; Ponzilacqua, B.; Coppa, C.F.S.C.; Hintzsche, H.; Sajid, M.; Cruz, A.G.; Corassin, C.H.; Oliveira, C.A.F. Aflatoxin in Foodstuffs: Occurrence and Recent Advances in Decontamination. Food Res. Int. 2018, 113, 74–85. [Google Scholar] [CrossRef] [PubMed]
- Liu, Y.; Wu, F. Global Burden of Aflatoxin-Induced Hepatocellular Carcinoma: A Risk Assessment. Environ. Health Perspect. 2010, 118, 818–824. [Google Scholar] [CrossRef] [PubMed]
- International Agency for Research on Cancer/World Health Organization. Cancer Today. Available online: https://gco.iarc.fr/today/home (accessed on 28 March 2021).
- Resham, S. Why Hepatocellular Carcinoma (Hcc)’s Management and Control Is Challenging in the Developing Countries? Problems vs. Strategies. J. Integr. Oncol. S 2016, 1, 2. [Google Scholar] [CrossRef]
- McCullough, A.K.; Lloyd, R.S. Mechanisms Underlying Aflatoxin-Associated Mutagenesis—Implications in Carcinogenesis. DNA Repair 2019, 77, 76–86. [Google Scholar] [CrossRef]
- Ferreira, R.G.; Cardoso, M.V.; de Souza Furtado, K.M.; Espíndola, K.M.M.; Amorim, R.P.; Monteiro, M.C. Epigenetic Alterations Caused by Aflatoxin B1: A Public Health Risk in the Induction of Hepatocellular Carcinoma. Transl. Res. 2018, 204, 51–71. [Google Scholar] [CrossRef]
- El-Serag, H.B. Epidemiology of Viral Hepatitis and Hepatocellular Carcinoma. Gastroenterology 2012, 142, 1264–1273. [Google Scholar] [CrossRef]
- Kew, M.C. Hepatocellular Carcinoma in Developing Countries: Prevention, Diagnosis and Treatment. World J. Hepatol 2012, 4, 99–104. [Google Scholar] [CrossRef] [PubMed]
- Habibi, N.; Nassiri-Toosi, M.; Sharafi, H.; Alavian, S.M.; Shams-Ghahfarokhi, M.; Razzaghi-Abyaneh, M. Aflatoxin B 1 Exposure and the Risk of Hepatocellular Carcinoma in Iranian Carriers of Viral Hepatitis B and C. Toxin Rev. 2019, 38, 234–239. [Google Scholar] [CrossRef]
- Kew, M.C. Synergistic Interaction between Aflatoxin B1 and Hepatitis B Virus in Hepatocarcinogenesis. Liver Int. 2003, 23, 405–409. [Google Scholar] [CrossRef]
- Bbosa, G.S.; Kitya, D.; Odda, J.; Ogwal-Okeng, J. Aflatoxins Metabolism, Effects on Epigenetic Mechanisms and Their Role in Carcinogenesis. Health 2013, 5, 14–34. [Google Scholar] [CrossRef]
- Groopman, J.D.; Johnson, D.; Kensler, T.W. Aflatoxin and Hepatitis B Virus Biomarkers: A Paradigm for Complex Environmental Exposures and Cancer Risk. Cancer Biomark. 2005, 1, 5–14. [Google Scholar] [CrossRef]
- Monson, M.S.; Coulombe, R.A.; Reed, K.M. Aflatoxicosis: Lessons from Toxicity and Responses to Aflatoxin B1 in Poultry. Agriculture 2015, 5, 742–777. [Google Scholar] [CrossRef]
- Agbetiameh, D.; Ortega-Beltran, A.; Awuah, R.T.; Atehnkeng, J.; Islam, M.-S.; Callicott, K.A.; Cotty, P.J.; Bandyopadhyay, R. Potential of Atoxigenic Aspergillus Flavus Vegetative Compatibility Groups Associated with Maize and Groundnut in Ghana as Biocontrol Agents for Aflatoxin Management. Front. Microbiol. 2019, 10, 02069. [Google Scholar] [CrossRef]
- Lewis, M.H.; Carbone, I.; Luis, J.M.; Payne, G.A.; Bowen, K.L.; Hagan, A.K.; Kemerait, R.; Heiniger, R.; Ojiambo, P.S. Biocontrol Strains Differentially Shift the Genetic Structure of Indigenous Soil Populations of Aspergillus Flavus. Front. Microbiol 2019, 10, 1738. [Google Scholar] [CrossRef]
- Senghor, L.A.; Ortega-Beltran, A.; Atehnkeng, J.; Callicott, K.A.; Cotty, P.J.; Bandyopadhyay, R. The Atoxigenic Biocontrol Product Aflasafe SN01 Is a Valuable Tool to Mitigate Aflatoxin Contamination of Both Maize and Groundnut Cultivated in Senegal. Plant Disease 2020, 104, 510–520. [Google Scholar] [CrossRef]
- Ben Taheur, F.; Kouidhi, B.; Al Qurashi, Y.M.A.; Ben Salah-Abbès, J.; Chaieb, K. Review: Biotechnology of Mycotoxins Detoxification Using Microorganisms and Enzymes. Toxicon 2019, 160, 12–22. [Google Scholar] [CrossRef]
- Li, P.; Su, R.; Yin, R.; Lai, D.; Wang, M.; Liu, Y.; Zhou, L. Detoxification of Mycotoxins through Biotransformation. Toxins 2020, 12, 121. [Google Scholar] [CrossRef]
- Nešić, K.; Habschied, K.; Mastanjević, K. Possibilities for the Biological Control of Mycotoxins in Food and Feed. Toxins 2021, 13, 198. [Google Scholar] [CrossRef] [PubMed]
- Peles, F.; Sipos, P.; Kovács, S.; Győri, Z.; Pócsi, I.; Pusztahelyi, T. Biological Control and Mitigation of Aflatoxin Contamination in Commodities. Toxins 2021, 13, 104. [Google Scholar] [CrossRef] [PubMed]
- Pinton, P.; Suman, M.; Buck, N.; Dellafiora, L.; De Meester, J.; Stadler, D.; Rito, E. Practical Guidance to Mitigation of Mycotoxins during Food Processing. Report, Commissioned by the Process.-Related Compounds and Natural Toxins Task Force; ILSI Europe: Brussel, Belgium, 2019; ISBN 978-90-78637-45-5. [Google Scholar]
- Karlovsky, P.; Suman, M.; Berthiller, F.; De Meester, J.; Eisenbrand, G.; Perrin, I.; Oswald, I.P.; Speijers, G.; Chiodini, A.; Recker, T. Impact of Food Processing and Detoxification Treatments on Mycotoxin Contamination. Mycotox Res. 2016, 32, 179–205. [Google Scholar] [CrossRef]
- Bandyopadhyay, R.; Ortega-Beltran, A.; Akande, A.; Mutegi, C.; Atehnkeng, J.; Kaptoge, L.; Senghor, A.L.; Adhikari, B.N.; Cotty, P.J. Biological Control of Aflatoxins in Africa: Current Status and Potential Challenges in the Face of Climate Change. World Mycotoxin J. 2016, 9, 771–789. [Google Scholar] [CrossRef]
- Warnatzsch, E.A.; Reay, D.S.; Camardo Leggieri, M.; Battilani, P. Climate Change Impact on Aflatoxin Contamination Risk in Malawi’s Maize Crops. Front. Sustain. Food Syst. 2020, 4, 591792. [Google Scholar] [CrossRef]
- Cotty, P.J. Virulence and Cultural Characteristics of Two Aspergillus Flavus Strains Pathogenic on Cotton. Phytopathology 1989, 79, 808–814. [Google Scholar] [CrossRef]
- Adhikari, B.N.; Bandyopadhyay, R.; Cotty, P.J. Degeneration of Aflatoxin Gene Clusters in Aspergillus Flavus from Africa and North America. AMB Express 2016, 6, 62. [Google Scholar] [CrossRef]
- Moore, G.G. Practical Considerations Will Ensure the Continued Success of Pre-Harvest Biocontrol Using Non-Aflatoxigenic Aspergillus Flavus Strains. Crit. Rev. Food Sci. Nutr. 2021, 1–18. [Google Scholar] [CrossRef]
- Mauro, A.; Garcia-Cela, E.; Pietri, A.; Cotty, P.J.; Battilani, P. Biological Control Products for Aflatoxin Prevention in Italy: Commercial Field Evaluation of Atoxigenic Aspergillus Flavus Active Ingredients. Toxins 2018, 10, 30. [Google Scholar] [CrossRef]
- Savić, Z.; Dudaš, T.; Loc, M.; Grahovac, M.; Budakov, D.; Jajić, I.; Krstović, S.; Barošević, T.; Krska, R.; Sulyok, M.; et al. Biological Control of Aflatoxin in Maize Grown in Serbia. Toxins 2020, 12, 162. [Google Scholar] [CrossRef] [PubMed]
- Kabak, B.; Dobson, A.; Var, I. Strategies to Prevent Mycotoxin Contamination of Food and Animal Feed: A Review. Crit. Rev. Food Sci. Nutr. 2006, 46, 593–619. [Google Scholar] [CrossRef]
- Chavez, R.A.; Cheng, X.; Stasiewicz, M.J. A Review of the Methodology of Analyzing Aflatoxin and Fumonisin in Single Corn Kernels and the Potential Impacts of These Methods on Food Security. Foods 2020, 9, 297. [Google Scholar] [CrossRef] [PubMed]
- Siwela, A.H.; Siwela, M.; Matindi, G.; Dube, S.; Nziramasanga, N. Decontamination of Aflatoxin-Contaminated Maize by Dehulling. J. Sci. Food Agric. 2005, 85, 2535–2538. [Google Scholar] [CrossRef]
- Aly, S.E. Distribution of Aflatoxins in Product and By-Products during Glucose Production from Contaminated Corn. Food/Nahrung 2002, 46, 341–344. [Google Scholar] [CrossRef]
- Lefyedi, M.L.; Taylor, J.R.N. Effect of Dilute Alkaline Steeping on the Microbial Contamination, Toxicity and Diastatic Power of Sorghum Malt. J. Inst. Brew. 2006, 112, 108–116. [Google Scholar] [CrossRef]
- Raters, M.; Matissek, R. Thermal Stability of Aflatoxin B1 and Ochratoxin A. Mycotoxin Res. 2008, 24, 130–134. [Google Scholar] [CrossRef]
- Herzallah, S.; Alshawabkeh, K.; Fataftah, A.A. Aflatoxin Decontamination of Artificially Contaminated Feeds by Sunlight, γ-Radiation, and Microwave Heating. J. Appl. Poult. Res. 2008, 17, 515–521. [Google Scholar] [CrossRef]
- Ghanem, I.; Orfi, M.; Shamma, M. Effect of Gamma Radiation on the Inactivation of Aflatoxin B1 in Food and Feed Crops. Braz. J. Microbiol. 2008, 39, 787–791. [Google Scholar] [CrossRef]
- Di Stefano, V.; Pitonso, R.; Avellone, G. Effect of Gamma Irradiation on Aflatoxins and Ochratoxin A Reduction in Almond Samples. J. Food Res. 2014, 3, 113–118. [Google Scholar] [CrossRef]
- Stanley, J.; Patras, A.; Pendyala, B.; Vergne, M.J.; Bansode, R.R. Performance of a UV-A LED System for Degradation of Aflatoxins B1 and M1 in Pure Water: Kinetics and Cytotoxicity Study. Sci. Rep. 2020, 10, 1–12. [Google Scholar] [CrossRef]
- Vijayalakshmi, S.; Nadanasabhapathi, S.; Kumar, R.; Sunny Kumar, S. Effect of PH and Pulsed Electric Field Process Parameters on the Aflatoxin Reduction in Model System Using Response Surface Methodology: Effect of PH and PEF on Aflatoxin Reduction. J. Food Sci. Technol. 2018, 55, 868–878. [Google Scholar] [CrossRef] [PubMed]
- Bulut, N.; Atmaca, B.; Evrendilek, G.A.; Uzuner, S. Potential of Pulsed Electric Field to Control Aspergillus Parasiticus, Aflatoxin and Mutagenicity Levels: Sesame Seed Quality. J. Food Saf. 2020, 40, 1–12. [Google Scholar] [CrossRef]
- Masimango, N.; Remacle, J.; Ramaut, J.L. The Role of Adsorption in the Elimination of Aflatoxin B1 from Contaminated Media. Eur. J. Appl. Microbiol. Biotechnol. 1978, 6, 101–105. [Google Scholar] [CrossRef]
- Čolović, R.; Puvača, N.; Cheli, F.; Avantaggiato, G.; Greco, D.; Đuragić, O.; Kos, J.; Pinotti, L. Decontamination of Mycotoxin-Contaminated Feedstuffs and Compound Feed. Toxins 2019, 11, 617. [Google Scholar] [CrossRef]
- Food Drug Administration. Title 21—Food and Drugs. Available online: https://www.accessdata.fda.gov/scripts/cdrh/cfdocs/cfcfr/cfrsearch.cfm?fr=184.1155 (accessed on 9 May 2020).
- Doyle, M.P.; Applebaum, R.S.; Brackett, R.E.; Marth, E.H. Physical, Chemical and Biological Degradation of Mycotoxins in Foods and Agricultural Commodities. J. Food Prot. 1982, 45, 964–971. [Google Scholar] [CrossRef] [PubMed]
- Di Natale, F.; Gallo, M.; Nigro, R. Adsorbents Selection for Aflatoxins Removal in Bovine Milks. J. Food Eng. 2009, 95, 186–191. [Google Scholar] [CrossRef]
- Soufiani, G.R.N.; Razmara, M.; Kermanshahi, H.; Barrientos Velázquez, A.L.; Daneshmand, A. Assessment of Aflatoxin B1 Adsorption Efficacy of Natural and Processed Bentonites: In Vitro and in Vivo Assays. Appl. Clay Sci. 2016, 123, 129–133. [Google Scholar] [CrossRef]
- Diaz, D.E.; Hagler, W.M.; Blackwelder, J.T.; Eve, J.A.; Hopkins, B.A.; Anderson, K.L.; Jones, F.T.; Whitlow, L.W. Aflatoxin Binders II: Reduction of Aflatoxin M1 in Milk by Sequestering Agents of Cows Consuming Aflatoxin in Feed. Mycopathologia 2004, 157, 233–241. [Google Scholar] [CrossRef]
- Assaf, J.C.; Nahle, S.; Chokr, A.; Louka, N.; Atoui, A.; El Khoury, A. Assorted Methods for Decontamination of Aflatoxin M1 in Milk Using Microbial Adsorbents. Toxins 2019, 11, 304. [Google Scholar] [CrossRef]
- Aiko, V.; Edamana, P.; Mehta, A. Decomposition and Detoxification of Aflatoxin B1 by Lactic Acid. J. Sci. Food Agric. 2016, 96, 1959–1966. [Google Scholar] [CrossRef]
- Park, D.L.; Lee, L.S.; Price, R.L.; Pohland, A.E. Review of the Decontamination of Aflatoxins by Ammoniation: Current Status and Regulation. J. Assoc. Off. Anal. Chem. 1988, 71, 685–703. [Google Scholar] [CrossRef] [PubMed]
- Intanoo, M.; Kongkeitkajorn, M.B.; Suriyasathaporn, W.; Phasuk, Y.; Bernard, J.K.; Pattarajinda, V. Effect of Supplemental Kluyveromyces Marxianus and Pichia Kudriavzevii on Aflatoxin M1 Excretion in Milk of Lactating Dairy Cows. Animals 2020, 10, 709. [Google Scholar] [CrossRef] [PubMed]
- Tao, F.; Zhao, K.; Zhao, Q.; Xiang, F.; Han, G. A Novel Site-Specific Integration System for Genetic Modification of Aspergillus flavus. G3 Genes Genomes Genet. 2020, 10, 605–611. [Google Scholar] [CrossRef] [PubMed]
- Masanga, J.O.; Matheka, J.M.; Omer, R.A.; Ommeh, S.C.; Monda, E.O.; Alakonya, A.E. Downregulation of Transcription Factor AflR in Aspergillus Flavus Confers Reduction to Aflatoxin Accumulation in Transgenic Maize with Alteration of Host Plant Architecture. Plant Cell Rep. 2015, 34, 1379–1387. [Google Scholar] [CrossRef]
- Thakare, D.; Zhang, J.; Wing, R.A.; Cotty, P.J.; Schmidt, M.A. Aflatoxin-Free Transgenic Maize Using Host-Induced Gene Silencing. Sci. Adv. 2017, 3, 1–8. [Google Scholar] [CrossRef] [PubMed]
- Sharma, K.K.; Pothana, A.; Prasad, K.; Shah, D.; Kaur, J.; Bhatnagar, D.; Chen, Z.-Y.; Raruang, Y.; Cary, J.W.; Rajasekaran, K.; et al. Peanuts That Keep Aflatoxin at Bay: A Threshold That Matters. Plant Biotechnol. J. 2018, 16, 1024–1033. [Google Scholar] [CrossRef]
Publisher’s Note: MDPI stays neutral with regard to jurisdictional claims in published maps and institutional affiliations. |
© 2021 by the authors. Licensee MDPI, Basel, Switzerland. This article is an open access article distributed under the terms and conditions of the Creative Commons Attribution (CC BY) license (https://creativecommons.org/licenses/by/4.0/).